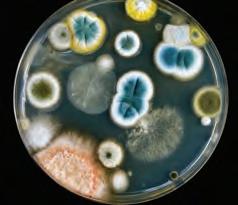

Achievers AWARDS




The University of Pretoria congratulates all our academic achievers.






![]()

Achievers AWARDS




The University of Pretoria congratulates all our academic achievers.






This year, the Academic Achievers awards ceremony is taking place under extraordinary circumstances. The world is in the midst of the COVID-19 pandemic and the University of Pretoria (UP) has not been left unscathed. As we all know, these awards celebrate UP’s drive to become a world leader in research activities. The current pandemic has necessitated that, as an educational and research institution, we up our game and face this challenge head on.
To heed government’s call to flatten the curve, at the time of writing this message all students and staff were working from home. However, some of our personnel are directly involved in the international effort to minimise the damage caused by this coronavirus. UP’s Department of Family Medicine developed a highly efficient COVID-19 screening protocol that provides holistic health support to communities in need. A team from UP’s Department of Statistics, in collaboration with a partner in the Middle East, developed what is believed to be the first interactive app in the country to provide real-time data on COVID-19 using R-Shiny (a statistical software package).
The University’s Chief Operations Officer and his team negotiated with major national telecommunications providers to assist our students with zero-rated data to enable them to access learning materials and platforms for free. A senior member of UP’s Faculty of Economic and Management Sciences (Prof. Willem Fourie) was seconded to the Presidency to assist with initiatives aimed at combatting COVID-19. In addition, two UP students developed a mobile app for homeless shelters to access assistance during the pandemic.
It is actions such as these that ensure that UP continues to shine as an innovative university. This explains why the University has improved its overall ranking in three of the four broad subject areas that the institution was ranked in, according to the QS World University Rankings by Subject 2020. The rankings, which were released earlier this year, noted that UP is the domestic leader in the fields of Theology, Divinity and Religious Studies, Electrical and Electronic Engineering, and Veterinary Science. Social Sciences and Management is UP’s strongest field according to the ranking. UP also managed to improve its ranking in eight subjects.
The efforts of all our staff, including those profiled in this publication, ensure that UP is squarely on the path to attain its vision of being a leading research-intensive university in Africa, recognised for its quality, relevance and impact, and also for developing people, creating knowledge, and making a difference locally and globally. Our top-class academics consistently achieve outcomes that place us among the top-performing research institutions in Africa.
According to the Department of Higher Education and Training (DHET) 2018 research output report UP’s academic staff top the log. We have the highest number of permanently appointed academics who hold a doctoral degree (839) as their highest qualification. This means 69.6% of UP’s academic staff hold a doctoral degree, while another 28.4% hold a master’s degree. The national average of staff with doctorate degrees sits at 48%. This is a great accolade and achievement, not only for the individuals but for the institution as a whole.
I would like to send a special thank you to all of you for your continuous efforts to achieve research that matters. It is your collective efforts that help us to ensure that we produce academics and professionals that are equipped with the skills to produce quality research and research that will provide solutions to Africa’s problems.


Professor Tawana Kupe Vice-Chancellor and Principal | University
Professor Achille Mbembe is a prominent figure in the fields of African history, politics and social science. The Cameroonian philosopher obtained his PhD in History from the Sorbonne in Paris in 1989, and a DEA in Political Science from the Institut d’Études Politiques—also in Paris. He was an assistant professor of history at Columbia University, New York (1988-1991), a senior research fellow at the Brookings Institute in Washington, DC (1991-1992), associate professor of history at the University of Pennsylvania (1992-1996) and executive secretary of the Council for the Development of Social Science Research in Africa (CODESRIA) in Dakar, Senegal (1996-2000). He was also a visiting professor at the University of California, Berkeley (2001), Yale University (2003), the University of California at Irvine (2004-2005), Duke University (2006-2011) and Harvard University (2012).
He is the recipient of an honorary doctorate from the University of Paris 8 (France) and the Université Catholique de Louvain (Belgium). He has also held the Albert the Great Chair at the University of Cologne (2019) and was an honorary professor at the Jakob Fugger-Zentrum, University of Augsburg (Germany). He has received numerous awards including the 2015 Geschwister Scholl-Preis, the 2018 Gerda Henkel Award and the 2018 Ernst Bloch Award.
A co-founder of Les Ateliers de la pensée de Dakar and a significant figure in the emergence of a new wave of French critical theory, he has written extensively on contemporary politics and philosophy, including On the Postcolony (University of California Press, 2001), Critique of Black Reason (Duke University Press, 2016), Necropolitics (Duke University Press, 2019) and Out of the Dark Night—Essays on Decolonization (Columbia University Press, 2020). Originally written in French, his books and numerous articles have been translated into 13 languages (English, German, Spanish, Portuguese, Italian, Dutch, Polish, Slovenian, Danish, Swedish, Romanian, Arabic, and Chinese). He has an A1 rating from the South African National Research Foundation and is a member of the American Academy of Arts and Sciences.


The Chancellor’s Award is made in recognition of exceptional achievement in the field of research aimed at the advancement of science, and the associated promotion of the interests of the University of Pretoria.



Professor Wiseman
Chancellor | University of Pretoria
Professor Jan Eloff holds the DRS Chair in Cyber-Security and is a full professor in Computer Science. He is the Deputy Dean: Research and Postgraduate Studies in the Faculty of Engineering, Built Environment and IT, and enjoys considerable international recognition for his research in safeguarding platforms against societal and organisational cyber threats. He is a leading international scholar in the area of research into the convergence of cyber-security, Big Data and Data Science.
He is the co-inventor of a number of patents registered in the USA. He has published widely in leading international journals and in 2018 he published a scholarly book on software failure investigations. He was an associate editor of Computers & Security, the world’s leading journal for the advancement of cyber-security, and currently serves on the editorial boards of Information and Computer Security (Emerald) and Computer Fraud & Security (Elsevier). He is a member of the governing and advisory board of the UNESCO International Knowledge Centre for Engineering Sciences and Technology (UNESCO (IKCEST)). During his research career he represented South Africa as an expert on Technical Committee 11 (Information Security) IFIP and was a recipient of the IFIP Silver Core and Outstanding Services Award. He served as the South African representative on ISO (the International Standards Organisation) and as a former president of the South African Institute of Computer Scientists and Information Technologists (SAICSIT). In 2017 he received a SAICSIT award recognising him as an individual who has played a pioneering role in promoting computer science and information technology as academic disciplines in South Africa.


The University of Pretoria introduced the Vice-Chancellor’s Book Award to recognise and reward authors of scholarly books, monographs and collections. The prizes are awarded once a year in two categories, namely humanities and social sciences (broadly defined) or natural and applied sciences. In 2018 two awards, one in the humanities and social sciences, and another in the natural and applied sciences, were made.
A book is considered to be scholarly if it presents the findings of an original, systematic investigation undertaken to gain new knowledge and insight, advances knowledge in a particular discipline, and brings credit to the University. Scholarly books may be written in any of South Africa’s official languages, and translations of major works originally published in other languages are also considered. In order to qualify for nomination, books should bring credit to the University on account of their contribution to the advancement of the humanities, the social sciences, or the natural and applied sciences.




What is Africanness? Contesting nativism in race, culture and sexualities by Charles Ngwena. Pretoria University Law Press, Pretoria, 2018. Charles Ngwena is a professor of law at the Centre for Human Rights, University of Pretoria.
What is Africanness? Contesting nativism in race, culture and sexualities was written as an intervention in contemporary debates on the making of the African ‘race’, cultures and sexualities. It is a counter-discourse to articulations of Africanness that essentialise African identifications. The main question the book addresses is: Who/what is African? The book treats this question as a discourse question; instead of setting out to answer the question, it develops an interpretive method – the hermeneutics of Africanness – as its theoretical contribution towards deciphering inclusive Africanness.
What is Africanness is interdisciplinary in its argumentation. It uses feminism, historicity, Foucauldian approaches and cultural theory in conceptualising how we think about African identity in the construction of a hermeneutics of Africanness. Drawing from Stuart Hall’s cultural theory of identification, it is argued that when thinking about Africanness, dichotomous categories do not serve us well. Africannness is extraordinarily diverse. Africanness is situated in a multiplicity of histories, cultures and subjectivities that speak less to African identity in the way it has been espoused in colonial discourses and by ideologues of identity, and more to African identifications in the sense intended by Hall. The book focuses on developing and applying an interpretive method or hermeneutics for deconstructing African identity in ways that are deracialising and challenge historical discourses of reductive sameness. These discourses have overly focused on ‘race’ and racial thinking. As an analytic shorthand, the book describes this reductive sameness as ‘nativism’. It argues that nativism has dominated the imagination of African identity not just during the eras of slavery, colonialism and apartheid but also in contemporary times. The hermeneutics that What is Africanness develops are intended as decolonising, transformative theoretical tools for dismantling hierarchical systems of thought and unmasking gaps and contradictions in the imagination of African identity.
The conceptual framework for Africanness presented in this book is a deconstructive tool that should incline us towards detotalised enunciations in order to register radical historicisation and the constant process of change, transformation and positionality. It is a concept of identity better understood as identification; a situated constellation made up of multiple subjectivities, and an open, as opposed to closed, category. Apart from serving as a counter-discourse to nativising discourses, What is Africanness is also an attempt to fill a theoretical gap in African identity discourses. Much has been written about the generality of the African subject – its shared ‘public identity’. However, very little has been written about the African subject and its experience of radical uncertainty – its ‘lived subjectivity’, specificity, complexity and, above all, its plurality which, as Achille Mbembe, the philosopher and political theorist, emphasises, defies convergence towards a single trajectory. Ultimately, What is Africanness seeks to develop a theoretical archive of self-naming that enlarges the human freedoms of Africans. In a continuously racialising world, the book is a timely intervention. Its strategic relevance is both cultural and political. It has the potential to raise awareness about our interconnectedness, to transform stereotypes, shift public attitudes, and engender support for cultural, racial and sexuality justice. The book provides readers with a framework for avoiding slippage into dichotomous thinking. To borrow from Nancy Fraser, the feminist and critical theorist, What is Africanness defends only those versions of cultural, racial and sexuality identifications that can coherently be combined with the social politics of inclusive equality.

The Dark Side of the Hive by Robin Moritz and Robin Crewe. Oxford University Press, New York. 2018
Professor Robin Moritz is an extraordinary professor in the Department of Zoology and Entomology and was, until his retirement in 2019, professor of Molecular Ecology at the Martin Luther University of Halle-Wittenberg in Germany. Professor Robin Crewe is a senior research fellow at the Centre for the Advancement of Scholarship and is an Emeritus Vice-Principal of the University.
The Dark Side of the Hive synthesises their work on the life history of the honey bee, Apis mellifera, during a collaboration lasting 30 years. It highlights conflict rather than harmony, and failure rather than success from the perspective of the individual worker in the colony. When one looks carefully, the honey bee colony is far from perfect. As is the case in any complex social system, honey bee societies are prone to error, robbery, cheating and social parasitism. Nevertheless, the hive gets by remarkably well, despite many seemingly odd biological features that are often dismissed as aberrations, requiring us to focus attention on these ‘aberrations’, which are central to understanding aspects of social organisation.
The book dissects the various attributes of individual male and female honey bees and their roles in the colony. Colony organisation is driven by competition between individuals, using both physical force and chemical signalling. The authors show how this competition deals with handicaps that limit the use of physical force, and how chemical arms races drive competition in worker reproduction.
Attention is also paid to individual mistakes, maladaptations and evolutionary dead-ends that form part of the life of bees. The story told about these non-cooperative elements (the dark side of being a member of society) within the colony spans the full range of biological disciplines, ranging from genomics to systems biology. It provides a more complete insight into the nature of complex insect societies by focusing on individual contributions to this society.
As Mark Winston wrote in his review of the book: ‘There has been quite a bit of research into the dark and imperfect side of honeybees, but never before brought together into a single volume. Prior syntheses of honeybee biology, and particularly books written for public audiences, have emphasised societal cohesion rather than breakdowns. It is clear from this thoughtful volume that conflict and collaboration can exist side by side, and all social organisms express this fundamental tension between individual advancement and communal success. We humans fall into that conundrum, and by understanding honey bee societies, warts and all, we get the occasional glimpses into our own’ (Quarterly Review of Biology 92:292 (2019)).
In 2017 Professor Robin Crewe was included in the Academy of Science of South Africa’s book titled Legends of South African Science (DOI http://dx.doi.org/10.17159/ assaf.2016/0012). At the 2019 NSTF-South32 Awards Ceremony he was a finalist in two categories, namely Contribution over a Lifetime and Contribution through Management and Related SET Activities. He was the recipient of the former award. In the same year, he was awarded honorary life membership of the Entomological Society of Southern Africa.




This award is made annually to senior academics who have already achieved the status of professor, are regarded highly by their peers, and have consistently excelled in the areas of under- and postgraduate teaching and learning, research, community service and administration over a period of time. Any academic who has been awarded an A-rating by the NRF in the year under consideration automatically qualifies as an Exceptional Achiever for as long as he or she remains an A-rated researcher.




Professor Roumen Anguelov is a full professor and head of the Department of Mathematics and Applied Mathematics. His research is focused on areas of differential equation, their theoretical and numerical analysis, dynamic systems and mathematical modelling. Recently he has concentrated mainly on biomathematics, an interdisciplinary area that involves the application of mathematical methods and models to biological sciences, as well as new mathematical constructs and theory motivated by such applications. He collaborates with both local and international biologists and mathematicians.
His strong research links with CIRAD (the French Agricultural Research Centre for International Development) in France have been particularly fruitful with regard to mathematical modelling relevant to the controlling of pests, pathogens and vectors. He has been invited to make many presentations internationally, for example at the very prestigious Jacques Lois Lions Laboratory at the Pierre and Marie Curie University in Paris.
Prof Anguelov is a co-founder and editor-in-chief of the journal Biomath, which subscribes to the Fair Open Access Principles. As from 2019 the content of the journal has been indexed by Scopus.
Prof Anguelov received a B2 rating from the NRF.

Professor Dave Berger is a professor in the Department of Plant and Soil Sciences and leads the Molecular Plant-Pathogen Interactions research group at the Forestry and Agricultural Biotechnology Institute (FABI). As a plant biotechnologist, he conducts collaborative research on crop diseases of economic importance in Africa and globally. His research group interrogates grey leaf spot disease in maize as a model system to understand molecular mechanisms of plant host resistance and fungal pathogenicity. Genomics and data science approaches are employed to integrate and interpret field and laboratory data obtained from maize and the pathogen. His main research aim is to develop sustainable management strategies for long-term food security.
He was the recipient of the 2016 Special Award for Crop Science and Food Security awarded by the National Science and Technology Forum and South32.
He received a B2 rating from the NRF in 2019.


Professor Ian Craig is a professor and the Section Head of Control Systems in the Department of Electrical, Electronic and Computer Engineering in the Faculty of Engineering, Built Environment and Information Technology.
His main area of research is model-based control and optimisation in the process industries. The aim of his research is to help industries diminish their footprint on the planet and make processes more efficient by saving water and energy and reducing carbon emissions. He has also conducted research on the model-based control of diseases and disease networks, which has included the development of treatment strategies to reduce the disease burden in a population, and model-based analysis of HIV and the transmission of TB.
In September 2019 he received the Chinese Government Friendship Award, which was presented by Vice-Premier Liu He in Beijing as part of the PRC’s 70th-anniversary celebrations. He gave the South African Institute Of Electrical Engineers’ (SAIEE) 67th Bernard Price memorial lecture in September 2018. In 2017 he was appointed by the Central South University in Changsha, China, as Chief Academic Master of a Chinese Government 111 Project on ‘Intelligent Control and Decision Optimization for Manufacturing Processes’. In the same year he was also appointed as International Federation of Automatic Control (IFAC) Advisor, chair of the IFAC Foundation Board, and chair of the IFAC Publications Committee.
He was the recipient of a UP Exceptional Academic Achiever award in 2002, 2013, 2017 and 2020.


Professor Schalk Els is a full professor in the Department of Mechanical and Aeronautical Engineering in the Faculty of Engineering, Built Environment and Information Technology (EBIT), and heads the Vehicle Dynamics Group (VDG).
He joined the Department of Mechanical and Aeronautical Engineering at the University of Pretoria as a senior lecturer in 1999, completed his PhD in 2006, received a Y2 NRF rating in 2007, was promoted to associate professor in 2008, received a C2 NRF rating in 2012, and was promoted to full professor in 2016. In 2019 he was the recipient of the Teaching and Learning award for the Department of Mechanical and Aeronautical Engineering.
His research focus is on improving the dynamics of heavy vehicles driving on off-road terrain by making them safer and more comfortable and efficient. Research on large tyres and driving on rough terrains is a crucial element of this research. The research methodology relies heavily on experimental work, and the group uses world-class test equipment and software, much of which is unique and was developed in-house. This research, which is especially relevant for industries that play a key role in driving the economy such as transport, mining, agriculture and construction - represents a critical building block in the multi-disciplinary research efforts involving smart transportation, autonomy and the application of big data as the drivers of the Fourth Industrial Revolution. The research is continuously refocused on the most relevant topics in the field, such as advanced driver-assistance systems (ADAS). He is responsible for vehicle dynamics simulation and testing, as well as the conceptualisation and development of state-of-the-art experimental equipment. Several colleagues and students make modelling, optimisation, mechatronic and control contributions.
He is the International Society for Terrain-Vehicle Systems (ISTVS) Deputy General Secretary for Europe-Africa and also serves as the ISTVS Regional Secretary for Africa and as an editor for the Journal of Terramechanics
Prof Els received a B2 rating from the NRF.


Professor Stephan Heyns is a professor in the Department of Mechanical and Aeronautical Engineering in the Faculty of Engineering, Built Environment and Information Technology (EBIT), and the director of the Department’s Centre for Asset Integrity Management. This Centre focuses on the structural integrity of mechanical systems and explores various aspects of the asset life cycle, ranging from structural analysis and structural testing to condition monitoring, diagnostics and prognostics, and on using this information to make well-founded maintenancemanagement decisions.
His personal research focuses on machine and structural health monitoring using vibration-based condition monitoring, and he has a particular interest in monitoring under non-stationary conditions, human vibration and new vibration measurement techniques, including optical measurement techniques, as well as various other aspects of the broader physical asset integrity management problem.
He is the author or co-author of more than 127 peer-reviewed journal articles and more than 136 national and international conference papers, and has successfully supervised and/or co-supervised 87 master’s and 23 doctoral students.
He is a fellow of the South African Academy of Engineering, an honorary fellow of the SA Institution of Mechanical Engineers, a fellow of the International Society of Engineering Asset Management, and a fellow of the Royal Aeronautical Society.
Prof Heyns received a B3 rating from the NRF.

Professor Jenny M Hoobler is a full professor in the Department of Human Resource Management in the Faculty of Economic and Management Sciences (EMS). She is also the Department Doctoral Programmes Manager and co-coordinator of the EMS Doctoral Learning Programme in Management Sciences.
Prof Hoobler studies organisational behaviour, and focuses specifically on two areas, the first of which is understanding gender and diversity at work. At the microorganisational level she is interested in how perceptions of women employees’ caregiving roles and responsibilities limit their supervisors’ perceptions of these women’s career competency. One of her papers about finding these contemporary glass ceiling effects for women workers (bosses’ lower perceptions of promotability, fewer promotions earned) has garnered nearly 500 citations. She studied this phenomenon in Fortune 100 US companies using survey methodology.
At the macro-organisational level, her gender and diversity research has tested the often assumed business case for women leaders, i.e. the link between having more women leaders in a firm and various measures of that firm’s financial performance. In a study published in 2018, she and her co-authors from the University of Pretoria and the University of Illinois at Chicago (USA) found mixed support for the business case for women leaders.
Having more women leaders does seem to be positively associated with sales performance in particular, and having a female CEO was related to a combined measure of all types of firm financial performance, yet theoretical reasons for these links remain woefully lacking and models remain underspecified. She has studied the business case for women leaders via meta-analytic evidence from more than 118 000 organisations worldwide.
Recently Prof Hoobler’s gender and diversity work has taken a turn to focus not only on women at the top of the pyramid (leaders in organisations), but also lower-skilled women workers. Her current projects include an in-depth look at relations between career women and the domestic workers they employ, and implications for both partners’ work-life balance.
Prof Hoobler’s second stream of research underscores the workplace social problem of abusive supervision, that is, bad bosses. Nearly one third of all workplaces have a boss that can be considered psychologically abusive. Prof Hoobler has been active in this research area for nearly 20 years, and has published work focusing mainly on predictive factors of abusive supervision, but also on how the effects of having an abusive boss can spill over to significant others and children in the home. Over the years she has published more than 20 papers on this topic.
She has a Google Scholar h-index of 25 and her work has been cited nearly 4 500 times. In 2020 she became the first person from an African institution to become an associate editor of the top industrial psychology and management journal, the Journal of Applied Psychology (JAP). She is a member of the brain trust of the US-based non-profit organisation Catalyst, the leading think tank on women and work. In the past five years, Prof Hoobler and her research team have received more than R1 110 000 in grant funding from national and international sources.
Prof Hoobler received a B3 rating from the NRF in 2015.

Professor Willem Adolf Landman is a full professor in Meteorology in the Department of Geography, Geoinformatics and Meteorology (GGM) in the Faculty of Natural and Agricultural Sciences. He has worked in meteorology for more than three decades and has been associated with the Department as an extraordinary professor since 2005.
Before joining the Department in 2016 he first served as Chief Scientist at the South African Weather Service, and then as Chief Researcher at the Council for Scientific and Industrial Research (CSIR). Since joining GGM, he has been the project leader or co-leader of the following: an Alliance for Collaboration on Climate and Earth Systems Science (ACCESS) project investigating the predictability of seasonal anomalies for societal benefit; a Water Research Commission project on research-based assessment of integrated approaches to nature-based solutions, focusing on seasonal predictions system development for Vaal Dam management; an ACCESS-JST (Japan Science and Technology Agency) project on early warning systems for infectious diseases; and a Belmont Forum project addressing southern Africa’s hydro-economy and water security.
Since joining the Department, he has published more than 20 journal papers and has been recognised by the NRF for his invaluable contribution to the development of operational seasonal forecasting in South and southern Africa. His work has impacted on specific applications of seasonal forecasting, such as hydrology, agriculture and health in the region. In 2017 he established an operational seasonal forecasting entity at UP called Seasonal Forecast Worx, through which seasonal forecasts for southern Africa are distributed. These forecasts include rainfall and temperature forecasts for the region, malaria forecasts for the Limpopo province, dry-land crop-yield and rainfall forecasts for a number of farms in South Africa and Namibia, and inflow forecasts for Lake Kariba. Monthly forecasts of El Niño and La Niña events are also provided and are included in the ensemble of El Niño–Southern Oscillation forecasts administered by the International Research Institute for Climate and Society, which is part of the Earth Institute of Columbia University in New York, USA. He is an adjunct research scientist at this institution.


Professor Fanus Venter, a professor in the Department of Biochemistry, Genetics and Microbiology and Deputy Director of the Forestry and Agriculture Biotechnology Institute (FABI), is affiliated with the research programmes of the Tree Protection Cooperative Programme and the Centre of Excellence in Tree Health Biotechnology, which form part of FABI. The main focus of his research is bacterial evolution, systematics and diversity. He heads an active research programme in which, through the use of comparative genomics, an attempt is made to understand the functions, biology and evolution of bacteria associated with plants and aquatic environments. His particular interest is in the bacterial systematics of the nitrogen-fixing Paraburkholderia and Bradyrhizobium species isolated from indigenous legumes in South Africa. His group has already described several new species belonging to these genera.
His water-related research focuses on the bacterial ecosystem present in networks distributing drinking water. In an attempt to improve the management and operation of these systems, his research group is currently monitoring the presence and abundance of bacterial species in a community reservoir to demonstrate how the bacterial community changes in response to external factors such as water treatment, demand, temperature, and seasonality.
In addition to managing his research programmes, he serves on the Executive Board of the International Committee on Systematics of Prokaryotes and the Council of the Southern African Society for Systematic Biology. He was recently invited to act as guest editor for the third edition of Bergey’s Manual of Systematic Bacteriology, Enterobacteriaceae. He is also a member of the editorial board of the journal Systematic and Applied Microbiology and associate editor of the International Journal of Systematic and Evolutionary Microbiology. He has acted as supervisor or co-supervisor for 12 PhD and 45 MSc candidates.
Prof Venter received a B3 rating from the NRF.


Professor Frans Viljoen is a professor of law and Director of the Centre for Human Rights in the Faculty of Law.
His area of research is regional human rights protection, with particular emphasis on the African Union human rights standards, institutions and processes within their socio-economic and political context. He is the author of International Human Rights Law in Africa, which is one of the leading texts on the African human rights system.
As Director of the Centre for Human Rights he leads a number of teams that supported aspects of the mandate for special mechanisms of the African Commission on Human and Peoples’ Rights, in particular, the Special Rapporteur on the Rights of Women in Africa (through the development of reporting guidelines under the Protocol to the African Charter on the Rights of Women in Africa, and General Comments) and the Special Rapporteur on the Right to Freedom of Expression and Access to Information in Africa (through the development of the Model Law on Access to Information in Africa). He also oversees advocacy units and research on the rights of children, women and persons with disabilities, and on freedom of expression and access to information. Furthermore, he oversaw the introduction of two master’s programmes titled ‘Sexual and Reproductive Rights in Africa’ and ‘Disabilities Rights in Africa’, which were delivered through a blend of virtual and in-person teaching.
In 2000 he became the founding editor of the leading journal on human rights in Africa, the African Human Rights Law Journal, and has since then served as editor-in-chief for this publication. Since 2017 he has been serving as founding convening editor of the African Human Rights Yearbook /Annuaire africain des droits de l’homme.
He has served as visiting professor on the African human rights system at the University of Zimbabwe; Essex University, UK; UPEACE, Costa Rica; Addis Ababa University; Abo Akademi, Finland; the University of Oxford, UK; Universidade Eduardo Mondlane, Mozambique; the American University, Washington, DC, USA; Paris II, France; and the University of San Martin, Argentina.
A total of 33 doctoral students have graduated under his sole supervision, six of them in the past three years. He is currently supervising a further 15 doctoral students.
In 2019 he was elected as a deputy chairperson of the Global Campus of Human Rights, an institution that brings together, from across the globe, seven master’s programmes in the fields of human rights and democratisation.


This award is given to exceptional young achievers in the field of research, as seen against the University’s strategic goals of achieving academic excellence, international competitiveness and local relevance. Any person who has been evaluated by the NRF as a P-rated researcher automatically enjoys Exceptional Young Researcher status.




Professor Deane, who established the astronomy research group at UP in 2018, is an associate professor in the Department of Physics in the Faculty of Natural and Agricultural Sciences.
He is primarily a radio astronomer, but has significant experience across the electromagnetic spectrum. His research interests cover a wide range of energies and spatial scales, from diffuse neutral hydrogen in galaxies to the inner accretion disks of supermassive black holes. He is especially interested in strong gravitational lensing, binary supermassive black-hole systems, and black-hole shadow imaging with arrays of antennas spread across the planet. He strongly emphasises the matching of scientific objectives with the appropriate technical expertise, specifically in observational methods and probabilistic (Bayesian) analyses, and increasingly also on machinelearning algorithms.
Over the past three years his main focus has been on two themes relating to the further development of the astronomy research group at UP, namely the training of postgraduate students to enable them to carry out world-class science with South Africa’s new MeerKAT telescope (the precursor to the Square Kilometre Array) and the group’s role as a member of the international Event Horizon Telescope team that was the first to capture an image of a black hole. The latter was well covered by national and international media in 2019 and won the team several coveted awards, including the Breakthrough Prize for Fundamental Physics, the American Astronomical Society’s Bruni Rossi Award, and the Einstein Medal. Although these awards are greatly appreciated, what he is really looking forward to is seeing young members of his team winning awards for their research using cutting-edge telescopes, including the MeerKAT and the Square Kilometre Array, here on African soil.


Dr Michal Gwizdala is a postdoctoral fellow in the Department of Physics in the Faculty of Natural and Agricultural Sciences. In his research he explores the excitation energy flow regulatory mechanisms in photosynthetic apparatus to reveal how different components of this molecular machinery work together, and how these interactions influence photosynthetic processes and organisms. He combines advanced spectroscopic and biochemical methods with molecular biology to investigate molecular mechanisms in natural photosynthetic systems in vivo and in vitro, and to design, synthesise, engineer and study artificial photosynthetic pigment-protein complexes.
Dr Gwizdala completed his studies in the UK and in Poland, where he obtained an MSc in Biotechnology. Then, thanks to financing received from the EU FP7 Marie Skłodowska-Curie Actions ITN Harvest and his subsequent in vitro reconstitution of a photoprotective mechanism of cyanobacteria, he was awarded a PhD in Biology with the highest distinction by the University Paris-Sud in France. This was followed by a long-term fellowship granted by the European Molecular Biology Organization (EMBO) to pursue his research at the Vrije Universiteit Amsterdam in the Netherlands, where his focus shifted to spectroscopy. When he was offered a Claude Leon Foundation Fellowship he moved to South Africa to assist with the establishment of the research programme in molecular biophysics at the University of Pretoria. Through his collaboration with the University of Pennsylvania in the USA, Dr Gwizdala has also become a postdoctoral research associate in the Photosynthetic Antenna Research Center (PARC) of the US Department of Energy.
In the Department of Physics, Dr Gwizdala has been involved in the development of a single-molecule spectroscopy facility that makes it possible to observe and follow, in real-time, the molecular mechanisms and the dynamics taking place in individual pigment-protein complexes. This experimental setup was the first in Africa, and is globally unique. In his recent projects, in which he used single-molecule spectroscopy as his primary research tool, he characterised the physico-chemical properties of photosynthetic light harvesting complexes and discovered a novel class of photoregulatory mechanisms. Understanding of these mechanisms, which are behind the evolutionary success of photosynthetic organisms, is critical for the development of new bio-inspired molecular solutions for solar energy conversion. In the longer term he aims to develop and implement artificial photosynthetic molecular machinery that will turn present-day, non-photosynthetic micro-organisms into light-driven cellfactories for the production of desired products ‘from light’ in a clean and sustainable manner.
He has co-authored 17 peer-reviewed publications and three popular-science articles, and has participated in more than 45 conferences, seminars and workshops.
Apart from his passion for research he also enjoys skiing, hiking, swimming and exploring Africa.

Professor Lijun Zhang is an associate professor in the Department of Electrical, Electronic and Computer Engineering in the Faculty of Engineering, Built Environment and Information Technology. His research interest is in the improvement of the energy efficiency of industrial processes, power systems and transportation vehicles using energy optimisation and control system techniques. In recent years, his particular interest has been in renewable micro-grids and electric vehicles. Prof Zhang’s work is internationally recognised by both the industry and academia.
From 2014 to 2019 he was the incumbent of the Junior Energy Efficiency Chair, which is funded by Exxaro Resources Ltd, and from 2017 to 2019 he led research projects funded by Transnet SOC Ltd. Currently he is the principal investigator for two research projects funded by the NRF and the Royal Academy of Engineering UK.
He has published more than 25 research articles in highly reputable international journals, has presented papers at many conferences, and received the Best Poster Paper award at the 2017 International Federation of Accountants (IFAC) Control Conference Africa.
Prof Zhang received a Y2 rating from the NRF.

This award recognises the contribution of members of our academic staff who excel as supervisors of postgraduate research students. The award is made on the grounds of exceptional performance measured in terms of the students’ academic achievement. Evidence of excellent mentorship and guidance provided to young researchers and academic scholars is also taken into consideration.




Professor Don Cowan is a full professor in the Department of Biochemistry, Genetics and Microbiology in the Faculty of Natural and Agricultural Sciences. He is also the Director of both the Genomics Research Institute and the Centre for Microbial Ecology and Genomics.
He conducts research in the field of microbial ecology, with a primary focus on soil microbiomics. His specific interest in the microbial ecology of extreme environments, hot and cold desert ecosystems, in particular, has taken him to many remote parts of the world, including the Antarctic continent and the high Arctic, several of the world’s deserts, and remote parts of China, South America and Africa.
He has received various awards in recognition of his research activities. He is a fellow of the Royal Society of South Africa, a member of the Academy of Sciences of South Africa, and an honorary fellow of the Royal Society of New Zealand. He received the National Science and Technology Forum Capacity Development award in 2014, the University of Pretoria’s Chancellor’s Medal in 2015, and the Royal Society of South Africa’s John F W Herschel medal in 2019. He was elected as a fellow of the African Academy of Sciences in 2017.
Prof Cowan received an A1 rating from the NRF.


The Laureates are awarded to nominated projects that display teaching practices with clear purpose and intent, and which have a strong alignment between the different elements in the broader context, to address identified needs or gaps, with the aim of innovating to optimise teaching and learning.
These nominations show significant evidence of impact on student learning are sustainable, and can be replicated in other contexts. These projects contribute to best practice in teaching and display significant evidence of innovation that addresses the identified challenges.




Dr Rory Biggs is a senior lecturer in the Department of Mathematics and Applied Mathematics in the Faculty of Natural and Agricultural Sciences. His research focuses on the equivalence and classification of various (smooth) geometric structures.
Since his appointment at UP in 2017 he has been very active in promoting and driving excellence in teaching, and has taught two high-impact modules and implemented several innovations to encourage student engagement, create a supportive teaching and learning environment, and provide enrichment. These innovations include weekly podcasts during which course-related discussions between members of the lecturing team, video recordings of lectures, and online discussion boards enabling discussions between students and staff and between fellow students are made available.
In 2019 he received a Teaching Excellence Award from the Department of Mathematics and Applied Mathematics. He has been nominated three times by NATHouse (the Faculty of Natural and Agricultural Sciences student body) for a Best Lecturer Award, and has received resoundingly positive feedback from his students in his evaluations, for example: ‘Best lecturer ever. Papa Biggs is the GOAT (Greatest of All Time) (WTW114 2019).
He regards his role as a lecturer as an opportunity to act as his students’ guide on a grand adventure. His responsibility is to guide them through difficulties, offer support, give context to new encounters, kindle their interest and (especially) to share his enthusiasm and passion as they traverse new material.
He has co-authored more than 30 papers on research areas such as sub-Riemannian geometry, optimal control, Lie groups and Lie algebras, and Poisson spaces. His flagship contribution to the UP Teaching and Learning (T&L) community is the T&L@NAS Bulletin, which he conceived and created, and for which he is also the editor. The bulletin aims to serve as a forum for the UP T&L community to share thoughts, ideas and experiences.


Mr Roland Henwood
Mr Henwood completed his MA in Political Science at the University of Pretoria, where he is currently a lecturer in the Department of Political Sciences. His teaching focuses on areas of South African politics, policy and governance, strategic and security studies, and democratisation.
His research is concerned with security, governance, South African politics and policy. He has participated in research projects of the European Commission and universities in southern Africa and Europe, and has served as country specialist to the Royal Dutch Department of Foreign Affairs and Development Assistance. He also contributes to the policy environment and policy discussions through regular contributions to training and participation in the training programmes of various institutions and organisations.
He has presented lectures at universities in the USA and Australia and papers at national and international conferences, and regularly contributes to domestic and foreign printed and electronic media. His publications include journal articles in international and South African academic journals, an edited book, chapters in books, and reports.
In 2018 Henwood and Thuynsma were the joint recipients of the Faculty of Humanities’ Teaching and Learning award for their teaching of the Political Science honours module on Comparative Politics, which incorporates The Global Classroom.
Ms Heather Thuynsma
Ms Thuynsma completed a BA Honours at the University of the Witwatersrand and an MA in Applied Politics at the University of Akron (Ohio, USA). She subsequently attended the Women’s Campaign School at the Yale Law School to complete her specialisation in fundraising and political campaign strategy. She spent 25 years working in the South African and US nonprofit sectors, where she was involved in managing fundraising, policy analysis, and media relations. During South Africa’s first democratic elections in 1994 she worked as a specialist election monitor, has coordinated and raised funds for political campaigns at various levels of government in the State of Ohio, and has taught political behaviour, campaign management, fundraising strategy and civic and human rights education in both the US and South Africa. She has published articles on human rights education for the United Nations, and on South Africa’s political campaigns and electoral strategy for the Electoral Institute of South Africa. She is currently the Communications Manager for the Faculty of Humanities, and also supervises postgraduate students and co-teaches the honours-level course on Comparative Politics, which incorporates The Global Classroom, with Roland Henwood in the Department of Political Sciences. In 2018 this postgraduate course won the Faculty of Humanities’ Teaching and Learning award.
She has been a contributing editor of two book-length publications, titled Public Opinion and Interest Group Politics: South Africa’s Missing Links? and Political Parties in South Africa: Do they undermine or underpin democracy?, and co-edited, with Professor Vasu Reddy (Dean: Faculty of Humanities), the monograph The Undiscovered Country: Essays in Honour of Maxi Schoeman
Ms Thuynsma has presented papers at several international conferences and, before joining the Faculty as its Communications Manager, advised political parties and advocacy groups in Angola, Cote D’Ivoire, the Democratic Republic of the Congo, Ethiopia, Ghana, Kenya, Lesotho, Malawi, Mozambique, Namibia, Senegal, South Africa, Tanzania, Uganda, the US, Zambia and Zimbabwe.


Mr Roland Henwood and Ms Heather Thuynsma
Dr Nadia M Trent (PrEng) was a senior lecturer in the Department of Industrial and Systems Engineering. During her three years at UP, she piloted the Vertically Integrated Projects (VIP) programme in the Faculty of Engineering, Built Environment and Information Technology (EBIT), which had been established in close collaboration with the Georgia Institute of Technology and the global VIP Consortium.
VIP teams are small, vertically integrated, transdisciplinary research and development teams of only eight to 12 members who work on real industry or research problems under the mentorship of a faculty member (team leader). Students from the second year of study to PhD level may join these teams for a minimum period of one semester, but ideally they are encouraged to commit to the team for two years, to reap the full benefit of the learn–contribute–lead growth cycle. Self-regulated learning, collaborative learning and mentorship fuel the fires in these teams and provide a learning experience that is quite unique on campus.
Apart from being recognised as the first VIP programme coordinator, she has achieved other teaching and learning accolades. In 2019 she received her department’s Teaching and Learning award, and in October 2019 she presented her teaching innovations in engineering economics at the EBIT Teaching and Learning symposium. She also completed her Postgraduate Certificate in Higher Education cum laude during 2019. While passionate about her teaching, Dr Trent returned to academia primarily to extend her research. Her main interest is in the quantitative modelling of freight transport systems, with the aim of informing policy and infrastructure decisions at the national level. She completed her PhD in this field in 2018 and has secured a number of early career grants to sustain her momentum.
Dr Trent and her family recently emigrated to New Zealand, where she will be continuing her academic career at the University of Waikato.

The Community Engagement Award is awarded annually to one individual to recognise community engagement as a long-standing and valued tradition in higher education, and an extensive, high-impact practice in teaching at the University of Pretoria.
The criteria for the award are aligned to those for the MacJannet Award, which is internationally administered by the Talloires Network.




Professor Christiaan Bezuidenhout is attached to the Department of Social Work and Criminology in the Faculty of Humanities, where he teaches psycho-criminology, criminal justice and contemporary criminology at the undergraduate and postgraduate levels. He holds the following degrees: BA (Criminology), BA Honours (Criminology), MA (Criminology) and DPhil (Criminology), as well as an MSc in Criminology and Criminal Justice from the University of Oxford.
He is the coordinator of the honours degree programme in Criminology at the University of Pretoria. Together with an American colleague, he has completed a cross-cultural study focusing on the legal and policing dilemmas encountered in human trafficking.
He has published numerous scientific articles in peer-reviewed journals and has contributed chapters to several books. He has also acted as editor-in-chief for various scholarly works. His latest book, titled A Southern African Perspective on Fundamental Criminology (2nd ed.), was published by Pearson in February 2020. He has participated in national and international conferences, has been actively involved in various community engagement projects focusing on crime prevention, and has assisted the South African government with the development of different crime-prevention and security initiatives (eg for the 2010 FIFA World Cup hosted by SA). He was the president of the Criminological Society of South Africa (CRIMSA) from 2015–2017.
In addition to his academic position he is currently the Head of Asterhof residence, the oldest female residence at the University of Pretoria. He serves on the South African Police Service Tertiary Institutions Cluster for Training and is a Director on the Board of the Hatfield City Improvement District (CID). He offers his forensic expertise as a witness in court, and compiles forensic court reports for legal counsel.
Professor Bezuidenhout received a C3 rating from the NRF and he has been selected as a Fulbright South African Research Scholar for the 2020-2021 academic year in the United States of America.


A-rated researchers
B-rated researchers
C-rated researchers
P-rated researcher
Y-rated researchers





Professor Lubuma, former Dean of the Faculty of Natural and Agricultural Sciences, is an emeritus professor who currently holds a contract appointment as professor in the Department of Mathematics and Applied Mathematics. His research interests include the numerical analysis of differential equations, with the emphasis on models that arise in engineering, science and life science, specifically the epidemiology of human infectious diseases. He has published widely in several prestigious journals and has attended several major conferences on topics relating to his field. He has made significant contributions to the theory of nonstandard finite difference schemes, and to the design of reliable numerical schemes for models that arise in applications. He has also contributed to making science work in Africa.
He has trained many postgraduate students, is involved in several regional research programmes, and has established the first-ever South African student chapter of the prestigious Society for Industrial and Applied Mathematics. He renders a vital service to the scientific community through his extensive involvement as associate editor and referee for several journals. In recognition of his contributions he has been appointed as a fellow of the African Academy of Sciences, and received the Sign of Honour of the Bulgarian Academy of Science and the South African Mathematical Society Award for Research Distinction (2011). He is also a Member of the Academy of Science of South Africa.

Professor Ogude is the Director of the Centre for the Advancement of Scholarship (CAS) and the principal investigator in a supra-national project, which is funded by the Mellon Foundation and involves the University of Ghana, Makerere University, the University of Cape Town, and the University of Pretoria.
He was also the principal investigator in a five-year project on the concept of ubuntu. His research interests include African literature written in English, and postcolonial theories, with a specific focus on issues of memory and the reconstruction of African history and identities. During the past decade he has studied popular cultures and literature in Africa, and, more recently, his research focus has shifted to postcolonial ecologies.
In 2019 he became the second resident scholar from Africa to serve as co-chair of the Theme and Programme Committee during the annual meeting of the African Studies Association held in Boston. He was recently appointed to the International Advisory Board of the Consortium for Humanities Centres and Institutes. The Centre for the Advancement of Scholarship is one of the very few African members of this organisation.
He is the author of the highly regarded text Ngugi’s Novels and African History, and has published a total of eight edited volumes and an anthology of African stories.
Prof Ogude received an A2 rating from the NRF.

The current research of James Raftery, professor in the Department of Mathematics and Applied Mathematics, involves the use of algebraic methods in logic. This work has two aspects. First, there is a concrete aspect, where algebraic methods illuminate particular deductive systems, thereby solving logical problems that had resisted other approaches. This frequently reduces to analysing mathematical objects called ‘residuated structures’. The logics modelled by these structures vary in their motivations—which include reasoning about different modes of truth or provability, about computation, and about grammatical structures in language. Secondly, there is the classification of deductive systems in general, and the identification of key properties that make them susceptible, in varying degrees, to algebraic treatment. In both endeavours, the methods of universal algebra are widely applicable. A more detailed picture is emerging of the distinct ways in which familiar logics can be strengthened, and of the distribution of desirable logical properties among them.
Prof Raftery was the 2014 recipient of the South African Mathematical Society’s Award for Research Distinction. He is the author or co-author of 65 published or accepted articles. He has supervised the dissertations of five PhD students (including one current) and five MSc students, as well as the Honours projects of eight students (including one current).
Professor Raftery received an A2 rating from the NRF.
Professor Wingfield holds the DST/NRF SARChI research chair in Fungal Genomics and is a professor in the Department of Biochemistry, Genetics and Microbiology. She is a member of the Forestry and Agricultural Biotechnology Institute Management Committee, the vice-president of the Academy of Science of South Africa, and secretary general of the International Society of Plant Pathology. Her research interests include fungal population genetics, phylogenetics and genomics.
Her research team was responsible for sequencing the first fungal genome in Africa, and in the past decade they have sequenced hundreds of fungal genomes, using this genomic data to pioneer functional gene characterisation studies in many fungal tree pathogens. She has acted as advisor or co-advisor to more than 50 master’s and 50 PhD students, and currently advises nine MSc and eight PhD students. She has published more than 400 peer-reviewed articles, has an ISI h index of 50, is a project leader in the DST/NRF Centre of Excellence in Tree Health Biotechnology, and serves on the editorial boards of the journals Fungal Biology and IMA Fungus.
She has received many awards, the most recent being the South African Society of Microbiology Gold Medal in 2018, which she was the first female recipient of.
Prof Wingfield received an A2 rating from the NRF.
Professor Fioramonti is full professor of Political Science in the Department of Political Sciences and the founding director of the Centre for the Study of Governance Innovation. His areas of research are political economy, regionalism, sustainable development, the metrics of wellbeing, governance, and innovation. His recent significant achievements include being invited to deliver keynote addresses at international events focusing on sustainable development, for example the Conference of Parties of the UN Framework Conference on Climate Change in Madrid, where he appeared side by side with the former US Secretary of State, John Kerry. He has advised the governments of Scotland, New Zealand and Iceland on wellbeing-centred economic policies, and has inspired the creation of the global forum WEGo. He promoted the Italian, German and Chinese translations of his books, which were reviewed by newspapers such as the Financial Times and The New York Times, and by Bloomberg.
Prof Fioramonti has published a number of articles and papers, including the opening chapter in The Quality of Growth in Africa, the latest book by Nobel Laureate Joseph Stiglitz. In 2018 he was appointed Deputy Minister and then Minister of Education, University and Research in Italy – a position he held until December 2019. During his term in office he introduced mandatory lessons on sustainable development and climate change in all schools, and promoted the study of sustainability as a cross-cutting subject at universities.
Prof Fioramonti received a B2 rating from the NRF.
Dr Hancke is an extraordinary senior lecturer in the Department of Electrical, Electronic and Computer Engineering in the Faculty of Engineering, Built Environment and Information Technology, and an associate professor in the Department of Computer Science in the School of Engineering at the City University of Hong Kong. His research interests are system security, resilient communication, and distributed sensing application, especially in the context of the Industrial Internet of Things (IIoT).
He acted as chair of the IEEE IES Technical Committee on Cloud and Wireless Systems for Industrial Applications from 2017 to 2018. In 2019 he received the J David Irwin Early Career Award from the IEEE Industrial Electronics Society (IES) for ‘research and educational contributions and impact on secure and reliable technology for the Industrial Internet of Things’. This award recognises young researchers who have made significant contributions in the field of industrial electronics within the first 10 years in their profession. In the same year he also received the Best Paper award at the IEEE International Conference on Industrial Informatics (INDIN) and the Best Paper award for the IEEE Industrial Electronics Magazine
Dr Hancke received a B1 rating from the NRF.




Professor Maina is a full-time professor in the Department of Civil Engineering in the Faculty of Engineering, Built Environment and Information Technology (EBIT). He specialises in the research and development of transport infrastructure engineering, particularly the numerical modelling of road and airport pavement responses to traffic loading for structural design, analysis and evaluation, mechanical characterisation - laboratory testing, artificial neural network (ANN) modelling of road construction materials, pavement maintenance and management systems (Infrastructure Asset Management - quality assurance and quality control (QA/QC) systems in road projects, and software development, including high-performance computing (HPC), for pavement engineering applications.
Prof Maina is a Fellow of the South African Institution of Civil Engineering (SAICE) and served as chair of the Annual Southern African Transport Conference (SATC) (2016, 2017, 2018, 2019, 2020). Furthermore, he is a member of the Standing Committee on Pavement Condition Evaluation, the Transportation Research Board (TRB), and the National Academies of Sciences, Engineering and Medicine, USA (2019 - 2022). He has been appointed as adjunct professor at Chang’an University, Xian City, China (2018 - 2021), adjunct professor at Shandong Jianzhu University, Shandong, China (2018 - 2023), vice-chairperson of the Board of Directors of the Belt and Road International Transport Alliance (BRITA), Beijing, China (2020), and international principal investigator for Smart Pavements Australia Research Collaboration (SPARC) Hub, Australia (2019 onwards).
Prof Maina received a B3 rating from the NRF.

Professor Malan is an associate professor in the Department of Mining Engineering in the Faculty of Engineering, Built Environment and Information Technology. He is also the Director of the Mining Resilience Research Centre and acting holder of the Harmony Gold Chair for Rock Engineering and Numerical Modelling.
His specific area of research is the numerical modelling of mine workings and rock failure, strength of mine pillars and stope support for the mining industry. Recent advances included the use of a limit equilibrium model to simulate the face crushing in deep gold mines, and the re-assessment of the effectiveness of stope support in such mines following the rock-burst disasters in the gold-mining industry.
In 2017 he was invited to present the International Society of Rock Mechanics Franklin Lecture – an honour bestowed on a mid-career ISRM member who has made a significant contribution to a specific area of rock mechanics. He was awarded the South African National Institute of Rock Engineering’s Salamon Prize for best paper in 2018, and received a silver medal from the South African Institute of Mining and Metallurgy in 2019. In 2020 he was invited to present the 29th International Society of Rock Mechanics lecture online.
Prof Malan received a B2 rating from the NRF.

Professor Tladi is a professor in the Department of Public Law and a Fellow of the Institute for Comparative and International Law in Africa. He is also interim SARChI Chair for International Constitutional Law.
In 2016 Prof Tladi was re-elected to the UN International Law Commission. He serves as Special Rapporteur for the topic Peremptory Norms of General International Law (jus cogens). His work on jus cogens formed the basis of the International Law Commission’s draft conclusions on peremptory norms of general international law. He was elected to the Institut de Droit International in 2017. In 2018 he was appointed to the panel of experts advising the High Level Panel on the Blue Economy.
Prof Tladi was invited to deliver a lecture at the prestigious Hague Academy of International Law. He is a regular lecturer at United Nations Regional Courses on International Law presented in Addis Ababa, Chile and Bangkok.
In 2018 Prof Tladi appeared as counsel on behalf of the African Union before the Appeals Chamber of the International Criminal Court.
Until 2018 he served as co-editor-in-chief of the South African Yearbook of International Law, and he remains on the editorial boards of several international law journals.
Prof Tladi received a B1 rating from the NRF.
Professor Van Aarde, who was a professor in New Testament Studies in the Faculty of Theology and Religion for 25 years, is currently a senior research fellow in the Dean’s office. He holds three doctoral degrees, DD, PhD and D Litt, and an MA in Semitic Languages.
He is an internationally renowned Bible scholar and an expert in the field of classical Greek and Roman literature. His numerous scholarly publications are characterised by the use of a variety of scientific methods and techniques, and he contributes in particular to the expansion of knowledge of the historical, social and cultural contexts of the New Testament writings.
His outstanding scholarship has earned him three awards from the South African Academy of Science and Arts. He is editor-in-chief of the Web of Science ISI and the Scopus-accredited scholarly journal HTS Theological Studies, and commissioning editor of AOSIS Scholarly Books. In 2020 Cambridge Scholars Publishing published the two volumes of his book titled Jesus, Paul and Matthew (Volume 1: Discontinuity in content and continuity in substance [476 pp] and Volume 2: To and from Jerusalem [464 pp]).
Prof Van Aarde received a B3 rating from the NRF.
Dr Adetunji is a senior lecturer in the Department of Industrial and Systems Engineering in the Faculty of Engineering, Built Environment and Information Technology.
His main areas of research are the planning and control of production/manufacturing systems, and the organisation and performance measurement of supply chain systems. He teaches Operations Management at the undergraduate level and Models of Manufacturing Planning and Control at the postgraduate level. He serves on the SAP Africa Academic Board and coordinates the teaching and certification of UP students in SAP ERP systems education.
His current research thrust is in intelligent planning and control techniques for enterprise systems. This area of research seeks to understand how artificial intelligence techniques and the internet of things can be adapted to fit into extant production planning and control algorithms to create intelligent decision-support systems for manufacturing planning, general supply chain process alignment, and performance management in business systems. This research should assist in the development of self-adapting planning and control capabilities in Enterprise Resource Planning (ERP) systems to simulate higher-order human thinking processes in a machine environment, in order to facilitate real-time planning and control decisions for strategic and operational purposes in enterprise planning and control systems.
Dr Adetunji received a C3 rating from the NRF.
Dr Angu joined the University of Pretoria in 2016 as a senior lecturer in the Unit for Academic Literacy. He obtained a PhD from the University of Witwatersrand for a narrative study of selected African refugees’ memories of forced displacement and the challenges of belonging in South Africa. His research interests have therefore been influenced by the politics of migration in post-apartheid South Africa, and years of lecturing academic and professional literacies at different universities.
In the area of migration, his research focuses primarily on the intricate relationship between displacement and emplacement, African migrant experiences, xenophobia/ Afrophobia, and the politics of belonging. He has also done some research on the academic reading and writing challenges experienced by undergraduate students, student agency, and the politics of curriculum decolonisation in South African universities. In this regard he is interested in understanding how hegemonic Western epistemologies and the marginalisation of African knowledge systems in university curricula continue to influence black students’ agency in higher education. He therefore views his main research activities as located within the core areas of African transnational migration and the related social configurations, curriculum decolonisation and academic/ professional literacies.
Dr Angu received a C2 rating from the NRF.




Professor Barker currently coordinates the Professional Master’s Architecture programme and teaches first-year Construction in the Department of Architecture, Landscape Architecture and Interior Architecture. He also coordinates the Department‘s Heritage and Cultural Landscapes Research Field and Design stream, and chairs the Research Committee. He is also the chair of the Education Committee of the Pretoria Institute of Architects. He has been an external examiner at eight universities and universities of technology in South Africa. He is a South African Council for the Architectural Profession Validation Board member.
Three principles guide his attitude to research: Prof Barker is an architect and designer of the built environment who wishes to improve the local spatial condition. He is a pedagogue who focuses on design teaching. He is also a curator of South African architectural heritage through participation in his Departmental Architectural Archive. His aim is to record South African architecture and critically analyse it so that it becomes useful for contemporary design. Prof Barker has been invited by three international publishers to write about South African architecture, especially the architects Karl Jooste and Pius Pahl, and Dutch architecture in South Africa from 1901-1961. In 2019 he was nominated to the international Canberra Accord Accreditation panel. In October 2019 he visited Taiwan to assess their architectural accreditation systems.
Prof Barker received a C2 rating from the NRF.

Professor Bauer is an extraordinary professor in the Department of Electrical, Electronic and Computer Engineering in the Faculty of Engineering, Built Environment and Information Technology.
Her research focuses on the automation of production processes for the chemical, petrochemical and mineral processing industry. In the context of the Fourth Industrial Revolution, she applies data-analytical methods to improve production efficiency and safety. Her expertise in performance monitoring of industrial controllers spans all controllers ranging from single-loop to model-predictive controllers and advanced strategies. She teaches both MBA students and educators about industrial robotics and how our lives will be affected by the increase in automation technology.
Her projects address industry-relevant problems, such as the auto-tuning of control loops using cutting-edge methods. Recently she has developed an interest in the design and operation of rainwater harvesting systems to address water shortages. If managed correctly, simple automation and operation strategies can dramatically improve the use of rainwater to supplement municipal water supplies. She is actively involved in outreach activities within the control engineering and automation community and in educational research and heads the activity fund committee of the International Federation of Automation and Control. She is a member of the diversity and inclusion task force, as well as the industry committee.
Prof Bauer received a C1 rating from the NRF.

Professor Chikwanda is an associate professor in the Department of Engineering and Technology Management in the Graduate School of Technology Management (GSTM) in the Faculty of Engineering, Built Environment and Information Technology (EBIT).
Her main area of research is operations management, with a specific focus on continuous improvement and the sustainability of operations, and her research interests include lean thinking, theory of constraints, supply chain, and operations strategy and improvement. She teaches operations management in the following programmes: Engineering and Technology Management (ETM), Engineering Management (MEM) and Technology and Innovation Management (TIM). She is active in continuous education, and has successfully supervised postgraduate students.
She has published extensively, and is a fellow of the Institute of Materials, Minerals and Mining (IMO3) and a member of the Minerals, Metals and Materials Society (TMS).
Prof Chikwanda received a C2 rating from the NRF.
Professor Cromarty is an associate professor in the Department of Pharmacology. His primary research thrust focuses on analytical method development for both small molecules and proteomics using liquid chromatography tandem mass spectrometry. The small-molecule based assays include many drugs, drug metabolites and biomolecules of both endogenous and exogenous origin that have a bearing on the outcome of drug treatment. He has mentored eight doctoral and more than 25 master’s students in mostly LC-MS/MS techniques with several of them achieving academic and prestige awards.
Prof Cromarty is regularly requested to review journal submissions including Journal of Chromatography A, Journal of Chromatography B, SA Journal of Botany, South African Journal of Science, Journal of Ethnopharmacology, BMC Complementary and Alternative Medicine, Natural Resources Research Journal, African Journal of Traditional, Complementary, and Alternative Medicines, Journal of Applied Microbiology and Letters in Applied Microbiology.
He is a member of the Chromatography Society of South Africa, South African Association for Mass Spectrometry (present chairman), South African Society for Basic and Clinical Pharmacology and Pharmacology for Africa Initiative as well as the South African Society of Biochemistry and Molecular Biology.
Prof Cromarty received a C2 rating from the NRF.
Professor Dada is a professor in the Centre for Augmentative and Alternative Communication (CAAC) in the Faculty of Humanities, and was recently appointed as the Director of the Centre. Through her research she seeks to systemically describe, understand and address the communication and participation patterns of persons with complex communication needs. Her particular focus is on how graphic symbol-based augmentative and alternative communication (AAC) systems can be used to facilitate language learning for individuals with complex communication needs, so as to facilitate their participation in society.
She has adopted a systems approach to her research. At the microsystem level, her research has addressed the iconicity of graphic symbols, characteristics of graphic symbol-based AAC systems, and the effect of aided input strategies designed to facilitate language learning in both children with developmental disabilities and adults with aphasia. Her research also investigates the mesosystems of persons with complex communication needs by focusing on the perspectives of communication partners, family members, teachers and health care professionals regarding the implementation of AAC. At the macro-system level, her research is concerned with practices and policies relating to AAC systems, and the availability and acceptability of those systems to individuals with complex communication needs.
Prof Dada received a C1 rating from the NRF.
Professor De Jager is Dean of the Faculty of Health Sciences. He is professor of Environmental Health in the School of Health Systems and Public Health (SHSPH), and extraordinary professor of Andrology, Department of Urology, School of Medicine.
Prof De Jager is the Director of the University of Pretoria Institute for Sustainable Malaria Control (UP ISMC) and South African Medical Research Council Collaborating Centre for Malaria Research. He is also the South African primary investigator of an international inter-sectorial and multidisciplinary team that aims to integrate skills and research designs and methods to investigate the effects of environmental toxicants on male reproductive health.
Prof De Jager is an internationally recognised researcher in his field. He has an extensive record of accomplishment of knowledge dissemination, student supervision and project management. Currently his various research projects focus on reproductive toxicology and environmental health, issues that are globally relevant in a climate of rapid population growth and increasing urbanisation. The quality and standard of his research has been recognised through various awards and invitations to present plenary lectures. As Director of the UP ISMC he and his team won the 2017/2018 NSTF-South32 Communication for Outreach and Creating Awareness of Science and Technology and Innovation Award.
Prof De Jager received a C1 rating from the NRF.




Professor De Villiers is an associate professor in the Department of Science, Mathematics and Technology Education, Faculty of Education. He is currently teaching pre- and in-service life and natural sciences teachers. Prof De Villiers is involved in various research projects, some of which involve international affiliations. His interdisciplinary research focus areas are inter- and intra-continental teacher migration studies, teacher training for life sciences education, and community-based service learning.
Prof De Villiers’ topical work on teacher migration represents some of the most quoted studies in the Faculty of Education. In 2019 he received the international Science-Made-Sensible Award from Miami University in the United States. This award acknowledges and recognises his ten-year involvement in the USA Science-Made-Sensible programme presented in some South African schools.
Prof De Villiers received a C2 rating from the NRF.

Professor Dreyer teaches Practical Theology, and is the acting head of the Department of Practical Theology in the Faculty of Theology and Religion. Her areas of research are gender, power, sexuality and pastoral engagement, pastoral theology and psychology, and theory formation in practical theology, which is the discipline that focuses on faith practice.
Throughout history, religious institutions and faith communities have often failed to create a safe and inclusive space for all people, including women and sexual minorities. This is still the case, and her research investigates the underlying theological, cultural, psychological and systemic causes of exclusive attitudes and practices, which are harmful to people and go directly against the message of inclusion, hope, dignity and wholeness that religious institutions want to convey. Much of the PhD work done under her supervision focuses on issues of gender and sexual equality in various African contexts, where some traditional values and practices tend to perpetuate systemic gender and sexual inequality.
She has been a member of a Princeton-based research group, New Directions in Pastoral Theology, for several years. She serves on the expert panel for theology and religion of both the European Science Foundation and the National Research Foundation of South Africa.
Prof Dreyer received a C1 rating from the NRF.

Professor Duncan is an emeritus professor in the Department of Systematic and Historical Theology in the Faculty of Theology and Religion.
Prior to his retirement and the merger with the Department of Dogmatics and Christian Ethics he headed up the Department of Church History and Church Polity. From 2014–2019 he was a post-retirement professor focusing mainly on research. He continues to provide postgraduate supervision. He has been involved in the evaluation of private higher education institutions for the Council on Higher Education and has been a panel member and convener of the Theology and Religious Studies panel of the National Research Foundation. He also teaches at St Augustine’s Roman Catholic College and at the Baptist Theological Seminary of South Africa.
His areas of research are missiology and the history of Christianity, and his research is concerned with the history of mission, theological education, ecumenism and Presbyterianism. In all of these his primary focus is South Africa.
Prof Duncan received a C3 rating from the NRF.
Dr Du Toit is a senior lecturer in the Department of Town and Regional Planning in the Faculty of Engineering, Built Environment and Information Technology. His critical interest is in the area of social sciences methodology aimed at improving the rigour and relevance of built environment research (i.e. architecture, construction, housing and urban planning and design). His epistemic interest is in the relationship between people and the environment, particularly with a view to creating sustainable built environments that facilitate human wellbeing and pro-environmental behaviour.
He was recently appointed as a research fellow in the Centre for Research on Evaluation, Science and Technology at Stellenbosch University, where he will undertake research into the social impact of urban planning research in South Africa. He played an instrumental role in the recent inclusion of the University of Pretoria as one of 48 partnering universities in the German-funded Global Center of Spatial Methods for Urban Sustainability at the Technical University Berlin. He is a professional planner registered with the South African Council for Planners, and serves on the research ethics committees of the Council for Scientific and Industrial Research, and the Faculty of Engineering, Built Environment and Information Technology at the University of Pretoria.
Dr Du Toit received a C3 rating from the NRF.
Professor Du Preez is a professor in Visual Culture Studies in the School of the Arts, Faculty of Humanities.
During the past eight years her research focus has capitalised on previous research on embodiment and new technologies, by focusing mainly on the phenomenon of the selfie as the epitome of contemporary human interaction with digital technologies. For her, the intellectual challenge is always to inquire about the status of materiality, embodiment, the feminine and, of late, the Earth, in relation to immateriality, disembodiment and the denigration of the feminine. Whether she poses this question through the aesthetics of the sublime versus the beautiful, the visible as opposed to the invisible, or the self in time and space as opposed to the self(ie) in real time, she is working through a phenomenological hermeneutic framework that understands embodiment as a non-negotiable aspect of being human. By identifying the selfie as a uniquely democratising instrument in creating digital agency, it is positioned as both a continuation of the tradition of self-portraiture, and a divergent strategy. In her research the selfie is thus treated as being simultaneously part of visual history and a rupture from the mimetic tradition.
In recognition of her research outputs she has twice been awarded the University of Pretoria Researcher of the Year award (Arts Cluster, Faculty of Humanities) in 2013 and 2016, and in 2015 she received a Teaching Excellence Award as the Lecturer of the Year in the Faculty of Humanities. She was the editor of Voices from the South: Digital Arts and Humanities, published in 2018.
Prof Du Preez received a C2 rating from the NRF.
Dr Dyson is a meteorologist and a senior lecturer in the Department of Geography, Geoinformatics and Meteorology in the Faculty of Natural and Agricultural Science.
Clear evidence exists that climate change has led to an increase in severe weather events. Such events need to be forecast in the short term (hours to days ahead) to be able to issue warnings that will save lives and property. In South Africa a gap has been identified in respect of short-term weather forecasting research, especially of severe weather events. It is in this niche that Dr Dyson conducts her research. Her contribution to research in South Africa thus far has been the establishment and expansion of research to improve short-term weather forecasting. The first approach in this regard is to develop an understanding of the processes of weather events and then to develop techniques for more reliable prediction. This often includes creating climatologies and investigating the dynamics before finally creating conceptual models or methods for forecasting severe weather.
She received the Water Research Commission’s (WRC) Knowledge Tree Innovation Award, which celebrates outstanding design, process and product development of innovative technologies, for the WRC project titled ‘The Impact of the Predictability of Continental Tropical Lows on Hydrological Modelling: Current State and Future Projections’.
Dr Dyson received a C2 rating from the NRF.




Professor Forbes is an associate professor in Analytical Chemistry at the University of Pretoria. Her research, which is focused on the development of novel sampling and analytical methods for environmental pollutants, includes novel denuder-based sampling techniques allowing for the simultaneous sampling of gas- and particle-phase organic air pollutants; the use of lichens as biomonitors of inorganic and organic air pollutants; and the development of quantum dot nanomaterials for fluorescence sensing of emerging chemical pollutants (such as pharmaceuticals and pesticides) in water.
She has published more than 60 articles in journals and has contributed eight chapters to books. Prof Forbes was awarded the prestigious 2019 ChromSA Chromatographer of the Year award in recognition of her research achievements, and was also the recipient of the Chemical Education award of the South African Chemical Institute (2014), the Wharton QS Reimagine Education Award for Presence Learning (2015), and the University of Pretoria Teaching Excellence and Innovation Laureate award (2016).
Prof Forbes assists the International Organisation for Standardization (ISO) as an expert in the monitoring of organic vapours in workplace environments. She also serves on the executive committees of a number of professional chemistry societies, and the editorial boards of four international chemistry journals.
Prof Forbes received a C1 rating from the NRF.

Professor Fourie is an extraordinary professor in the Department of Medical Microbiology in the Faculty of Health Sciences, where he leads several large-scale projects on tuberculosis, mostly with international collaboration and funding. He is a principal investigator in the MRC’s Collaborating Centre for Tuberculosis Biomarker-targeted Interventions (Lead: Hatherill, UCT) and the MRC Unit on Antimicrobial Resistance (Lead: Dheda, UCT), and serves on the International Council of Affiliate Members of the Autophagy, Inflammation and Metabolism (AIM) Centre, University of New Mexico, USA. Notably, he serves on the core group of eight experts in the proposal review committee of Unitaid, and has contributed to several WHO tuberculosis guideline documents on multi-drug-resistant tuberculosis and diagnostics. He is currently making novel contributions in the field of inhaled therapies for the treatment of tuberculosis, in particular the pulmonary delivery of drugs and vaccines. He also pursues innovative approaches to the simplification of molecular-based profiling for tuberculosis, and is engaged in international efforts to identify biomarkers of risk for TB. In 2018 he was a finalist in the NSTF Lifetime Achievement Awards category. His scientific contributions to peer-reviewed scientific journals and textbooks number more than 130.
Prof Fourie received a C1 rating from the NRF.

Professor Gaspar is an associate professor in the Department of Biochemistry, Genetics and Microbiology in the Faculty of Natural and Agricultural Sciences and currently also chairs the Division of Biochemistry and leads the Biotherapeutics Research Group.
Her main research area is the discovery and development of antimicrobial agents to address the problem of antimicrobial drug resistance. Antimicrobial peptides are key components of the innate immune system of a huge variety of living organisms and have the ability to eradicate infection. An understanding of their structure-activity relationships and modes of action is essential for the development of novel antimicrobials.
A Newton-funded, SA–UK project (2020–2022) will focus specifically on developing peptide-based antibiotics targeting gram-negative resistant pathogens.
To date she has either supervised or co-supervised 22 MSc and five PhD students, as well as one postdoctoral fellow, and currently she is supervising another four MSc and two PhD students. She has published 28 articles in peer-reviewed international journals ,and her research has been presented at local and international conferences. She is a member of the European Peptide Society and has served on the council of the South African Society of Biochemistry and Molecular Biology.
Prof Gaspar received a C2 rating from the NRF.
Professor Groenewald is a professor in the Department of Old Testament and Hebrew Scriptures in the Faculty of Theology and Religion. The main focus of his research is the book of Isaiah (chapters 1–12), studied through the lens of trauma theory.
The textual analysis seriously considers the historical embeddedness of the text of the book as the product of a long and complicated process of transmission. It is rooted in the concreteness of human history and can be adequately understood only if it is considered in that historical rootedness. Both synchronic and diachronic analyses of the text are retained as a synchronic analysis indicates the developmental history of Isaiah 1–12 in different layers. Although the chapters are presented as a single block of literature, a detailed analysis reveals that it is a composite work written over several centuries. Successive re-readings of the Isaianic tradition have been undertaken in the light of later historical and often traumatic circumstances. A key focus of his exegesis is the exploration of how trauma and resilience function in these texts.
Prof Groenewald received a C1 rating from the NRF.
Professor Isike is a professor of African politics and International Relations in the Department of Political Sciences, Faculty of Humanities. He is an immediate past vice president (2016 to 2018) of the South African Association of Political Studies (SAAPS), and currently one of four vice presidents (2018 to 2020) of the International Political Science Association (IPSA).
Prof Isike conducts research from an Africanist lens. He teaches international relations theory, strategic and security studies, and security theory. His research interests include African soft power politics, peace and conflict studies, women and political representation in Africa, rethinking state formation in Africa, and politics in a digital era.
Prof Isike was recently appointed editor-in-chief of Politikon: South African Journal of Political Studies (2020 to 2024) and has been editor of Ubuntu: Journal of Conflict and Social Transformation (2017 to 2020). Prof Isike serves on the editorial board of several reputable international journals, such as International Political Science Abstracts.
In 2008 Prof Isike – in collaboration with his doctoral supervisor at UKZN, Prof Ufo Uzodike – founded the Forum for Constructive African Scholarship (FCAS), a research think-tank committed to producing knowledge by Africans for Africa. In 2009 FCAS established Afrika: Journal of Politics, Economics and Society, which was accredited by IBSS in 2017.
Prof Isike received a C2 rating from the NRF.
Dr Joubert is an associate professor in the Department of Electrical, Electronic and Computer Engineering in the Faculty of Engineering, Built Environment and Information Technology, and the Acting Director of the Carl and Emily Fuchs Institute for Microelectronics, and Head of the Electronics and Microelectronics Group. She is a senior member of the IEEE and is registered as a professional engineer with the Engineering Council of South Africa (ECSA). She is actively involved in integrated circuit design and delivering prototypes and product chips for industry.
Her core research pursuit is CMOS and BiCMOS mixed-signal circuit design for readout and signal processing of imaging arrays, biologically inspired electronic circuits and sensor devices. Recently she has been focusing on the multidisciplinary integrated microelectronic sensor systems field, where the heterogeneous integration of microsystems is enabled by additive manufacturing-printed electronics in particular. Low-cost, flexible and smart electronic sensor devices and networks are applicable in sustainable environmental monitoring and diagnostics for resource-constrained settings.
She has been co-organising the biennial international conference on Sensors, MEMS and Electro-optical Systems (SMEOS) since 2009, and serves on the core committee of the national Nano-Micro Manufacturing Facility (NMMF) within the South African Research Infrastructure Roadmap (SARIR) programme of the Department of Science and Innovation.
Dr Joubert received a C2 rating from the NRF.



Dr Trudi Joubert

Dr Kritzinger is a senior lecturer and researcher in the Department of Plant and Soil Sciences in the Faculty of Natural and Agricultural Sciences. While his research activities integrate the fields of mycology, seed pathology and medicinal plant sciences, his main field of interest is the mycotoxin-producing fungi, the mycotoxins they produce, and their association with orphan crops.
He is particularly interested in the phytotoxic nature of various mycotoxins and investigates the mode of action of mycotoxins in cowpea (Vigna unguiculata) on the molecular, physiological and biochemical levels. Furthermore, he studies the antimicrobial and antiviral potential of extracts and isolated compounds from indigenous South African plant species to act against plant pathogens, in particular mycotoxin-producing fungi. The aim is to use plant extracts to develop botanical fungicides that can be used as an alternative, environmentally friendlier approach to prevent and control fungal infestation and mycotoxin contamination of grain in storage systems. Most of his research projects are aimed at ultimately contributing to enhancing food security among smallholder farmers and rural communities in South Africa and on the African continent.
Dr Kritzinger received a C2 rating from the NRF.

Professor Kuschke is an associate professor in the Department of Mercantile Law in the Faculty of Law, and the Director of the Unit for Insurance Law and Governance in her Department. She is an admitted and practising attorney, notary and conveyancer of the High Court of South Africa and specialises in the law of contract, insurance law, and construction and engineering law.
She joined the UP Faculty of Law in 1991 as a lecturer in the Departments of Private Law and Mercantile Law, and has also lectured extensively in both under- and postgraduate courses in the Faculty of Economic and Management Sciences and Faculty of Engineering, Built Environment, and Information Technology. She also served one term as Deputy Dean of the Faculty of Law. Since 2018 she has served as Vice-President: Academic Matters of the International Insurance Law Association, of which she had been a Presidential Council member since 2009. She was involved in studies undertaken by the Association, such as the Climate and Catastrophic Events Working Party, the Dispute Resolution and Consumer Protection Working Party, and the Pension and Collective Insurance Working Group.
She has published nationally and internationally, and is the author or co-author of a number of books. Her most outstanding achievement was her nomination as one of the 14 international principal drafting members in the international project on drafting universal principles for reinsurance contract law.
Prof Kuschke received a C2 rating from the NRF.

Professor Johan Labuschagne
Professor Labuschagne is an associate professor in the Department of Chemical Engineering in the Faculty of Engineering, Built Environment and Information Technology. He joined UP in 2009 after more than six years’ experience in the industry. During that time, he was involved in industrial research on the production of synthetic clays from run-of-mine raw materials, for which he also erected a pilot plant. After joining the University, he continued his research in that field. His current research focuses on the green synthesis of different layered double hydroxides and their applications in polymers, cosmetics, water treatment and as catalysts.
In recent years, his laboratory has achieved success with the use of these synthetic clays as catalysts in the production of biodiesel and other renewable fuels and pyrolysis oils. He is also a member of the team which designed and commissioned an IDC-funded pilot plant to produce some of these synthetic clays for the polymer market to potentially expand their activities to include the production of catalysts.
Prof Labuschagne received a C3 rating from the NRF.
Dr Lamola is a senior lecturer in philosophy at the University of Pretoria, where he researches and teaches postcolonial African Social Philosophy, the Philosophy of Technology and leads the Research Group on Africa, Philosophy and Digital Technologies (APDiT).
In addition to a PhD degree from Edinburgh University, he holds an MBA degree in technology investments management from Embry-Riddle Aeronautical University in Florida, USA. He is the founding member of the Centre for Phenomenology in South Africa and a senior research associate of the Institute of Intelligent Systems at the University of Johannesburg. His research mission is at the intersection of the dynamics of Africa’s appropriation of technology and her cultural and economic sovereignty.
He has published articles on topics ranging from Marxian epistemology and applications of the existential anti-colonial philosophy of Jean-Paul Sartre to contemporary African socio-ontological inquiries, specifically White Consciousness and Black Consciousness, and on the representation of Africans in the technologies of the Fourth Industrial Revolution. His latest publication in Ethics and Information Technology is titled ‘An ontic–ontological theory for ethics of designing social robots: a case of black African women and humanoids’ (2020).
Dr Lamola received a C2 rating from the NRF.
Dr Lenhardt is a senior lecturer in the Department of Geology in the Faculty of Natural and Agricultural Sciences. He studied at the Technische Universität Darmstadt, Germany, where he completed an MSc degree in 2005 and a PhD in 2009. In 2010, he joined the University of Pretoria as a postdoctoral researcher, and his appointment as lecturer followed in 2011.
As a sedimentologist and physical volcanologist, his research is traditionally field based and combines field, mapping and laboratory methods to decipher the formation of volcano-sedimentary sequences in Earth’s history from the Archaean to the Holocene Epochs. His research – conducted in many different countries, such as South Africa, Sudan, Tanzania, Cameroon, Nigeria, China and India – focuses on the effect of volcanic activity on sedimentation in volcano-sedimentary basins and the complex interplay between volcanic and sedimentary processes. The benefits of his research can be used not only for economic purposes, for example the characterisation of hydrocarbon reservoirs and base metal exploration, but also for hazard assessment in the respective areas.
To date he has published 28 articles in international peer-reviewed journals (many of those in collaboration with his students) and has an h factor of 11.
Dr Lenhardt received a C2 rating from the NRF.
Dr Lindsey is an extraordinary lecturer affiliated to the Mammal Research Institute in the Department of Zoology and Entomology. His research is focused exclusively on applied conservation biology.
He works on a range of topics related to conservation in Africa, including Africa’s protected area (PA) network. Under this banner, he has researched various topics, including assessments of the performance of PAs; estimates of the budget shortfalls facing PAs; strategies to improve PA management, for example via public-private partnerships between wildlife authorities and NGOs; and threats to Africa’s wildlife. Here a key focus has been on developing a better understanding of the illegal trade in bushmeat, which is one of the primary threats currently facing wildlife in Africa, and the conservation of predators, mainly lions and wild dogs. He has undertaken a significant assessment of the determinants of success in the field of lion conservation in Africa’s protected areas and the funding available for conservation. At present, he is researching the potential of carbon credits to generate funding for the protection of Africa’s wildlands.
Over the past three years, he has enjoyed extensive coverage of his research in international news media, including in publications such as The New York Times and The Economist.
Dr Lindsey received a C1 rating from the NRF.



Dr Peter Lindsey



Professor Lubbe, who previously headed the Tourism Management Division in the Faculty of Economic and Management Sciences, is a research associate in the Department of Historical and Heritage Studies in the Faculty of Humanities. To date, the primary focus of her research has been tourism distribution, more specifically, business travel as a specialised form of global tourism.
Her most recent paper, published in a special issue of Tourism Review, provides a perspective on the past and future of business travel. In the broader tourism field, she has been recognised for her work on the competitiveness of South Africa as a tourist destination and the development of a strategic framework for responding to mega-trends at a tourism sectoral level. She has published in numerous international journals and her books on tourism distribution and tourism management in South Africa have been widely prescribed.
She has received the University of Pretoria’s Laureate Award for her contribution to innovation in education and is a past board member of the International Federation for Information Technologies in Travel and Tourism (IFITT). She was awarded a doctorate in Communication Management for a thesis that focused on the Saudi Arabian image of South Africa as a tourist destination.
Prof Lubbe received a C2 rating from the NRF.
Professor Malan is professor of public law. He teaches aspects of Constitutional Law for the LLB degree and Constitutional Law for the coursework LLM degree in Constitutional and Administrative Law.
His primary areas of research are constitutional theory, including issues such as informal constitutional change (over and above formal constitutional amendment); the inadequacy of statist-individualist constitutionalism as demonstrated in various constitutional dispensations, including South Africa’s own unjustifiably vaunted constitution; a critique of the supremacy claims of the constitution; and the credibility of judicial independence and impartiality. Professor Malan is a member of the International Association of Constitutional Law, the Nederlands-Afrikaanstalig Wijsgerig Genootschap (South Africa, the Netherlands and Belgium), the Suid-Afrikaanse Akademie vir Wetenskap en Kuns and the International Academy of Language Law, and serves as a member of the editorial board of the International Journal of Language Law. He also participates in various international research groups.
He has published approximately 50 scholarly articles in local and international journals, recently, among others in the Journal of Humanities/Tydskrif vir Geesteswetenskappe (2018) and Chroniques de Droit Public - Publiekrechtelijke Kronieken (2018). He is the author of two scholarly monographs, namely Politocracy: an assessment of the coercive logic of the territorial state and ideas around a response to it (PULP, 2012) and There is no Supreme Constitution – A critique of statist-individualistic constitutionalism (African SUN Media, 2019).
Prof Malan received a C2 rating from the NRF.
Professor Markou is an associate professor in the Department of Civil Engineering, Division of Structures, Faculty of Engineering, Built Environment and Information Technology.
Prof Markou joined the University of Pretoria in 2018. Prior to that he worked for different universities, including the University of Sheffield in the United Kingdom, ALHOSN University in the United Arab Emirates, and Frederick University of Cyprus. In 2011 he was awarded a doctorate by the National Technical University of Athens, Greece, from where he also received his BSc and MSc degrees in the Department of Civil Engineering. He is the recipient of more than 15 academic awards and scholarships, and has two registrations as professional engineer (ETEK and ECSA).
His research involves subjects that deal with the seismic assessment and design of structures through advanced nonlinear simulations. Additionally, his research team focuses on developing design formulae through the use of artificial intelligence and machine learning algorithms. Through his research work he managed to develop and use state-of-the-art numerical tools that foresaw the study of the dynamic behaviour of wind turbine structures and nuclear reactor buildings with soil-structure-interaction considerations. Prof Markou is also involved with the modelling of ultimate limit state of composite and sustainable materials. He is also the software architect of Reconan FEA.
Prof Markou received a C3 rating from the NRF.
Professor Matthee is a professor and full-time faculty member of the Gordon Institute of Business Science. Her research focus is on exporting as an economic activity of South African regions and firms.
Her initial work centred on the investigation of the different elements of sub-national or regional exports, which included the determinants of exports and the importance of domestic transport costs, location and export composition. It soon became evident that a deeper understanding of exports was necessary. Her subsequent research outputs therefore focused on firm-level analyses under the broad topic of internationalisation, in particular the study of various firm-level export-related topics (such as offshoring and the gender wage gap).
At the Department of Science and Technology’s 2016 South African Women in Science Awards ceremony she was chosen as the second runner-up in the category Distinguished Young Woman Researcher: Humanities and Social Sciences. In 2017 she was a recipient of an award made in 2016 by the TRADE research entity at the North-West University for her role as co-author of the best research paper on a WTO-related topic (titled ‘South African Exporters and the GlobalCrisis: Intensive Margin Shock, Extensive Margin Hangover’).
Prof Matthee received a C3 rating from the NRF.
Professor Meiring, who passed away on 4 October 2019, was a professor in the Department of Human Resource Management in the Faculty of Economic and Management Sciences.
His reputation extended beyond the borders of South Africa, and his academic presence had a notable impact on the industry. He produced an extensive list of publications and taught Psychometrics and Advanced Assessment to third-year and master’s students, enriching the modules by using his expertise in the field of the cross-cultural implications of assessment centre practices in South Africa. He was the recipient of 14 competitive, peer-reviewed grants for various national and international research projects. In 2010 he received an award for his contribution to the enhancement of assessment centres in South Africa and in 2016 he was honoured by the Society for Industrial and Organisational Psychology of South Africa (SIOPSA) with a Presidential Award for his contribution to the field of industrial psychology in South Africa. In March 2018 he received special recognition for his significant scientific and professional contributions to assessment centre practices in South Africa.
His career success was attributed to his passion for cross-cultural psychology and assessment practices, as well as his unwavering commitment to enhancing the field of industrial psychology nationally and internationally.
Prof Meiring received a C1 rating from the NRF.
Professor Meyer is an associate professor in the Department of Paraclinical Sciences and the Director of the Centre for Veterinary Wildlife Studies in the Faculty of Veterinary Science. His areas of research include the behavioural and physiological consequences of veterinary management procedures in wildlife, particularly when animals are captured, translocated, reintroduced, rehabilitated or anaesthetised. He also has an interest in temperature regulation and the eco-physiology of free-living mammals, with a focus on how these animals are affected by climate change.
His research is primarily concerned with finding novel ways of reducing the side-effects of wildlife capture, with particular emphasis on threatened or endangered species such as rhinoceros. He received the South African Veterinary Association’s Research Award in 2017, and in 2018 his team received the Elsevier Award for an outstanding publication on rhinoceros anaesthesia in the Journal of Veterinary Anaesthesia and Analgesia.
Prof Meyer received a C1 rating from the NRF.




Professor Meylahn is a practical theologian in the Faculty of Theology. His latest research interests, philosophy and lived religion, bring philosophy, specifically critical theory, hermeneutics, metaphysics and phenomenology, into conversation with lived religion.
His current research project focuses specifically on expressions of religion understood mainly as lived religion, and therefore do not necessarily focus on institutionalised religion. The latter is, however, not excluded. Religious expressions in culture, such as movies, music, novels, advertising and architecture, are investigated. The research probes religious phenomena in society, such as new religious movements or new expressions of traditional religion, and religious violence. Religion and ethics are also considered and questions are asked concerning different religious interpretations of the rights of homosexuals, women and children. Religious tolerance and intolerance, religious challenges to pastoral care, religious challenges to community development/t ransformation (congregational studies) and religion and politics are also highlighted. The purpose of the project is to trace various aspects of religious transformation, and specifically the transformation of the Christian faith, how the age-old tradition or Word finds new expressions in multiple contexts, and how people respond to these expressions.
To date, he has published five books, 11 chapters in books, and 52 articles in scholarly journals.
Prof Meylahn received a C2 rating from the NRF.

Professor Moleleki is an associate professor in both the Department of Biochemistry, Genetics and Microbiology and the Forestry and Agricultural Biotechnology Institute.
She is the research leader of the Bacterial Genomics and Host Pathogen Interactions Research Group, which studies the phytopathogenic oomycetes, nematodes and bacteria that are mainly responsible for causing various diseases of potato plants. Her research has a two-pronged approach: she endeavours to understand the important virulence mechanisms of these phytopathogens while also aiming to understand the defence mechanisms elicited by bacteria in host plants. Functional genomic, transcriptomic and proteomic approaches are used in both these research areas. This research has led to the establishment of the importance of small non-coding RNAs in the virulence of soft bacteria, and the potential role of long, non-coding RNAs in potato plant defences.
To date, the research group has published more than 35 research papers in reputable journals such as Frontiers in Microbiology, Frontiers in Plant Sciences, Molecular Plant Pathology and Applied Environmental Microbiology, and their contributions have been cited by peers worldwide. The training of four postdoctoral fellows, five PhD and 10 MSc students has been completed, and the research group currently comprises five PhD and six MSc students.
Prof Moleleki received a C2 rating from the NRF.

Professor Naidoo is an associate professor in the Department of Electrical, Electronic and Computer Engineering (EECE) at the University of Pretoria. He is also Director of the South African National Energy Development Institute (Sanedi) Centre on Smart Grid Research and the Rand Water Chair in Electrical Engineering.
The electrical grid in South Africa is under increasing strain due to aging infrastructure and insufficient maintenance. Several research groups at the EECE are working with industry and government to address these challenges. Many of the projects and research programmes that are currently being pursued would not be possible without key collaborations between the School of Engineering and Sanedi, as well as other partner organisations. Prof Naidoo leads smart grid research in Sanedi, which has taken a two-pronged approach to boosting the electricity sector. Firstly, they develop smart metering technology for municipalities, and secondly, they develop technical standards for integrating smart grids and devices into the larger network.
Over the past three years Prof Naidoo has been awarded grants by Eskom, Sanedi, Powertech and Rand Water. He has published over 20 journal articles and conference papers and wrote three chapters in the book Power System Protection in Smart Grid Environment.
Prof Naidoo received a C2 rating from the NRF.
Professor Naraidoo is professor of economics in the Department of Economics, Faculty of Economic and Management Sciences.
His research areas are applied macroeconomic theory and policy. The main goals of his research are to understand agents such as consumers, firms and financial entity decisions in the marketplace, how in general equilibrium their behaviours explain aggregate macroeconomic variables, and to which extent macroeconomic policies can help improve societal outcomes.
In the pursuit of his primary goal Prof Naraidoo develops dynamic closed and open economy macro models in the nexus of financial and commodity markets with monetary and fiscal policy implications. These models are applicable to developing countries such as South Africa and other emerging market economies, and developed economies such as the Eurozone area, the United Kingdom and the United States.
His works have appeared in journals such as the Journal of Money, Credit and Banking, International Journal of Forecasting, Computational Statistics and Data Analysis, and the European Journal of Political Economy. He has also been awarded grants from the British Academy.
Professor Naraidoo received a C2 rating from the NRF.
Dr Newton is a senior lecturer in the Department of Immunology, Faculty of Health Sciences, and Deputy Director of the Centre for Neuroendocrinology.
Her research focuses on the molecular functioning and therapeutic potential of G Protein-Coupled Receptors (GPCRs). Her particular interest in unravelling the mechanisms underlying disease-causing genetic mutations in GPCRs has led her to explore how pathogenic GPCR variants may be informative of novel endocrine signalling pathways and how their dysfunction can be ‘rescued’ using novel small molecules that restore function (pharmacological chaperones).
One notable finding is her discovery of a molecule that restores function to mutations that give rise to poor cell surface expression, hormone-binding deficiencies or hormone-signalling deficiencies, which has never been demonstrated before. Her expertise in this area places her in a unique position as one of very few researchers worldwide currently involved in this exciting field of novel therapeutics for disease-causing GPCR mutations.
Her research spans biological disciplines – from cell biology and in vivo animal studies to human pre-clinical studies – and is supported by several research grants and national and international collaborations. She has been invited to present her research at prestigious international conferences and has received awards from scientific societies.
Dr Newton received a C3 rating from the NRF.
Dr Njoroge is a senior lecturer who presents undergraduate courses in the Engineering Augmented Degree Programme (ENGAGE) offered by the Faculty of Engineering, Built Environment and Information Technology.
His research focus is on investigating the reactions between some fission products and nuclear materials, and the characterisation of radiation-induced defects and their evolution after low- and high-energy bombardments. His particular research interest is in nuclear materials for application in Gen IV nuclear reactors and the encapsulation of nuclear waste. These nuclear materials, which include silicon carbide and glassy carbon, are characterised using the 2 MeV Van de Graaff accelerator, Raman spectroscopy, transmission and scanning electron microscopy to determine whether they are safe for nuclear applications.
He acts as supervisor to a number of masters and doctoral students, and has authored or co-authored more than 40 high-quality articles published in research journals. He has participated in joint research projects locally and internationally, and is a member of the IEEE, the South African Institute of Physics, and the South African Microscopy Society.
Dr Njoroge received a C3 rating from the NRF.



Dr Eric Njoroge

Dr Kenneth Oberlander is a senior lecturer and, since October 2018, the curator of the HGWJ Schweickerdt Herbarium in the Department of Plant and Soil Sciences in the Faculty of Natural and Agricultural Sciences.
Before joining UP he had held two postdoctoral research positions – one at Stellenbosch University, where he worked on the phylogeography of endangered vernal aquatic plants, and the other in Prague, in the Czech Republic, where his research focused on phylogenomics and flow cytometry. He currently studies the systematics and evolutionary patterns/processes in the South African flora, particularly the worldrenowned Cape flora, with sub-interests in taxonomy, plant anatomy and genome evolution (especially ploidy evolution). His interest in the last-mentioned led to an invitation to appear as guest speaker at the 5th Conference on Plant Genome Evolution held in Sitges, Spain, in October 2019. His research focuses on the species-rich angiosperm family Oxalidaceae, particularly the African radiation of the diverse and morphologically plastic genus Oxalis. He has named or co-named 13 new species of Oxalis, and has made contributions to multiple papers describing new fungus and insect species.
Dr Oberlander received a C3 rating from the NRF.

Dr Omidire is an associate professor in the Department of Educational Psychology, Faculty of Education. She is the Programme Coordinator for the MEd Educational Psychology programme and Chair of the Ethics Committee of the Faculty of Education.
Her research interests centre on multilingualism in education and its challenges, as well as the psychological wellbeing of affected students, teachers and parents. She is currently working on different projects in this field and exploring how multilingual education and translanguaging can be embraced as part of an asset-based approach to teaching and learning.
She received the Education Association of South Africa (EASA) Emerging Researcher Award 2019 and was nominated to the EASA Executive Committee in January 2020.
Dr Omidire received a C2 rating from the NRF.

Dr Petzer is an associate professor in the Department of Production Animal Studies in the Faculty of Veterinary Science.
Her main field of interest is udder health in dairy cattle, with a focus on proactive dairy herd udder health management decisions based on the microbiology and cytology of milk samples. She is currently involved in projects investigating emerging micro-organisms, including non-aureus staphylococci (NAS) and Streptococcus uberis, with a view to finding practical solutions for dairy farmers in South Africa and its neighbouring countries. Research on antimicrobial resistance in udder pathogens is also undertaken by using molecular and genetic analysis. New research aimed at the prevention of mastitis focuses on genetics and phytomedicine. She also has a keen interest in milking machine efficacy and the prevention of udder damage during milk harvesting. She heads a milk laboratory that provides relevant current material for research and offers a valuable service to dairy producers.
A highlight in her career was an invitation to present a keynote speech at the 2017 International Mastitis Conference held in Nantes, France.
Dr Petzer received a C2 rating from the NRF.
Professor Pillay is the Dean of the Faculty of Theology and Religion and professor in the Department of Systematic and Historical Theology. Prior to his appointment as Dean in March 2018 he headed the Department of Church History and Church Polity.
His main research focus is in the areas of African Christianity and development, in particular on African contributions to World Christianity and Early Christianity. As a result of the influence exerted by the Western World on Christianity in Africa, African culture, values, norms, religious understandings and spirituality have been side-lined. Any attempts made in the past to integrate the African way of life with the Christian Gospel were suppressed or written off as syncretistic. Even though today we have greater freedom of choice regarding religious practices, many people are slow to make the connections or venture into deeper research and understanding of the African contribution to Christianity.
In an attempt to break that barrier, he seeks to investigate Africa’s contributions to Christianity by focusing on the early church fathers, African-initiated churches, and developmental issues in Africa. As the former president of the World Communion of Reformed Churches, he also conducts research on what it means to be African and Reformed.
Prof Pillay received a C3 rating from the NRF.
Professor Rossouw, a professor in the Department of Immunology in the Faculty of Health Sciences, is a clinician scientist working in the field of human immunodeficiency virus (HIV) infection. She is also the deputy chairperson of the UP Faculty of Health Sciences Research Ethics Committee. Her research interests cover a wide spectrum, ranging from the basic sciences, where she focuses predominantly on HIV-associated drug resistance and systemic immune activation, to the clinical and social sciences, where she has been involved in exploring the management and socio-ethical aspects of HIV.
Her current research focuses on the immunological effects of exposure to HIV and the treatment of babies born to HIV-positive mothers, especially with regard to altered growth and neurological development. She also aims to develop an understanding of the potential toxicity and novel drug resistance pathways of a new class of antiretroviral medication.
Her research and clinical work has culminated in membership of the World Health Organization’s Research and Innovation Working Group of HIVResNet, as well as membership of various scientific committees, including the Southern African HIV Clinician Society Conference, the International Workshop on HIV Drug Resistance and Treatment Strategies, and the International Conference on Clinical Ethics and Consultation. She is the chairperson of the Research Ethics Committee of the Human Sciences Research Council.
Prof Rossouw received a C2 rating from the NRF.
Dr Schmulian, PhD, CA(SA) is an associate professor in the Department of Accounting in the Faculty of Economic and Management Sciences, and has taught accounting at both the undergraduate and postgraduate levels. She has received a Teaching Excellence and Innovation Laureate award from the University of Pretoria as well as a National Excellence in Teaching and Learning CHE and HELTASA award. She has supervised master’s and doctoral students, has presented papers at various prominent accounting and accounting education conferences, and serves on the editorial board of an A-rated accounting education journal.
Her specific field of interest is accounting education research, and she has published articles in the leading accounting education and higher education journals.
Dr Schmulian’s two most recent articles were published in the British Journal of Educational Technology, which is rated one of the top two educational technology journals, and in Assessment & Evaluation in Higher Education, one of the top five higher education journals. Her current research focuses on assessment for learning practices in a competency-based learning environment, and the use of technology to engage students. She is one of only a few South African researchers ranked on the Brigham Young Accounting Education Research Rankings, and has been rated by the NRF for her accounting education research.
Dr Schmulian received a C3 rating from the NRF.



Dr Astrid Schmulian


Dr Schoeman is a senior lecturer in piano and musicology in the School of the Arts, Faculty of Humanities. His research interests include historical musicology, didactics of piano playing, theoretical and stylistic analysis, and ethno-musicology.
Dr Schoeman, a Steinway Artist, has been awarded the first prize in the 11th UNISA International Piano Competition, the gold medal in the Royal Over-Seas League Music Competition in London, the contemporary music prize at the Cleveland International Piano Competition, and the Huberte Rupert Prize from the SA Akademie vir Wetenskap en Kuns. He has performed at the Wigmore, Barbican, LSO St Luke’s, Cadogan and Queen Elizabeth Halls in London, Carnegie Hall in New York, the Konzerthaus in Berlin, the Gulbenkian Auditorium in Lisbon, Teatro Vittoria in Turin, the Durban and Cape Town City Halls, and the Romanian Athenaeum in Bucharest. He has also performed at many festivals, such as the City of London, Edinburgh Fringe, Enescu, Grahamstown and Ottawa Festivals.
In 2016 he obtained a doctorate from City, University of London and the Guildhall School of Music and Drama. He has made several commercial recordings, and his performances are regularly broadcast on radio and television in South Africa and abroad.
Dr Schoeman received a C1 rating from the NRF.
Professor Smuts has been an associate professor in the Department of Informatics in the Faculty of Engineering, Built Environment and Information Technology since 2017. Prior to joining the University, she was involved in the promotion of digital transformation, driving growth through personalised digital offerings and empowering customers through convenient and effective self-service. Her thorough understanding of the digital and adjacent ecosystems also enabled her to implement digital financial solutions for the mass markets in South, East and West Africa.
Her current research focuses on information systems and the organisation, with particular emphasis on digital transformation, disruptive technologies (Fourth Industrial Revolution) and the management of big data and knowledge. The combination of these research areas enables cross-domain research in the field of knowledge visualisation as an organisational tool, as well as collaboration between human and machine knowledge (artificial intelligence and machine learning) for knowledge-related work. She is a member of a data-science research group that received a grant for building and presenting predictive models and dashboards for the forecasting of secondary-school success based on school, socioeconomic and community data points. This research group also collaborates with the University of Technology in Mauritius regarding service learning during community projects.
Prof Smuts received a C2 rating from the NRF.

Dr Stander is an associate professor in the Carl and Emily Fuchs Institute for Microelectronics, Department of Electrical, Electronic and Computer Engineering. His area of research is microwave and mm-wave microelectronics and systems. His current research interests include oscillation-based built-in self-testing for mm-wave microelectronics and the hybrid integration of mm-wave systems using additive manufacturing.
Prior to joining the Carl and Emily Fuchs Institute for Microelectronics in 2013, he had served as an RF engineer with Denel Dynamics (a division of Denel SOC Ltd). In his current position he established the first comprehensive mm-wave microelectronics metrology facility in sub-Saharan Africa, where more than 30 students have already been trained and which has produced more than 20 peer-reviewed publications and three patents since 2017.
The research conducted in his laboratory on active Q-enhanced mm-wave filters and non-uniform group delay microelectronic filters in SiGe BiCMOS has led to the establishment of Africa’s first mm-wave silicon IP start-up, Multifractal Semiconductors (Pty) Ltd, while recent work on mm-wave water vapour radiometry has led to new, low-cost instruments to support site surveying for mm-wave radio astronomy in Mexico and Namibia.
He is a former Erasmus Mundus scholar and a Senior Member of the IEEE.
Dr Stander received a C3 rating from the NRF.
Professor Steyn is a professor in the Department of Engineering and Technology Management in the Faculty of Engineering, Built Environment and Information Technology, where he specialises in Project Management and Project Portfolio Management.
Over the past three years Prof Steyn has co-authored nine papers that were published in accredited journals. These papers made novel contributions to project management – related fields such as project knowledge management, management of megaprojects, project scope readiness, and the impact of factors such as leadership, trust and collaboration on projects. Prof Steyn also co-authored a new edition of an international project management textbook that will be published in London and New York in 2020.
Prof Steyn supervised a doctoral study on the effect of project lifecycle phases and leadership style and co-supervised another doctoral study on the role of the sponsor of megaprojects. In both cases the doctoral degrees were awarded early in 2020.
Prof Steyn received a C2 rating from the NRF.
Professor Thantsha is an associate professor in Microbiology in the Department of Biochemistry, Genetics and Microbiology in the Faculty of Natural and Agricultural Sciences. Her research interests are in the broad field of bacteriology, with a particular interest in food microbiology.
Her research is focused on the functioning of the human gut microbiome and its effect on health, and the development of probiotics, prebiotics and synbiotics to enhance the functioning of the gut microbial system and for control of foodborne pathogens. In her research she explores different strategies, such as microencapsulation and stress adaptation to improve the stability of probiotic strains, develops alternative mechanisms for the delivery of such strains, and bioengineers probiotics for targeted control of enteric pathogens. She collaborates with other researchers on the application of probiotics in animal production, specifically small ruminant and poultry production. Furthermore, she is involved in projects that address the problems of water and soil pollution, where bio-remediation is used to make polluted soils suitable for crop cultivation, while the improvement of water quality ensures the availability of safe water.
Her research outputs include more than 30 peer-reviewed articles published in reputable national and international scientific journals, and two chapters in books. She contributes to human capacity development in Southern Africa, and has supervised or co-supervised 17 honours, 11 MSc and four PhD students.
Prof Thantsha received a C2 rating from the NRF.
Professor Tirvassen is a professor in and Head of the Department of Ancient and Modern Languages and Cultures in the Faculty of Humanities. In 1998 he received a PhD cum laude from the University of Provence (France). After defending his thesis in 2012 he was awarded a postdoctoral degree by the University of Rennes and University Jean Monnet, Saint Étienne, also in France.
Following an assessment of his research outputs in 2013 and 2017 his name was included on the list of professors for French universities established by the Ministry of Tertiary Education in France. Besides his tertiary experience gained in Mauritius he also taught French at the French Institute of London in 2002 and 2003. He spent some time as a visiting professor at the French University of New Caledonia.
He has conducted research in sociolinguistics and language acquisition on the islands of the South-West Indian Ocean. Over the past five years he has adopted a critical stance against what he terms traditional sociolinguistics. He has served on various national committees in Mauritius, including one established by the Government of Mauritius in 2003 to develop a writing system for Mauritian Creole to teach the language in primary schools on the island. His research is acknowledged both in Mauritius and on the Indian Ocean islands. In 2011 the Mauritius Research Council organised a national competition to identify the best Mauritian researchers, and he was placed among the top five.
Prof Tirvassen received a C2 rating from the NRF.



Professor Rada Tirvassen

Dr Van der Nest is an extraordinary lecturer in the Forestry and Agricultural Biotechnology Institute (FABI) and the Department of Biochemistry, Genetics and Microbiology in the Faculty of Natural and Agricultural Sciences, and a senior researcher at the Biotechnology Platform of the Agricultural Research Council (ARC). She uses classical genetics and mycology, combined with comparative genomic approaches, to study the biology, ecology and evolution of fungi, particularly those in the family Ceratocystidaceae.
After pursuing studies in the humanities (a BA Honours in Anthropology), she turned to the study of biological sciences and completed a BSc at UNISA, an MSc in Industrial Biotechnology at Newcastle University (UK) and a PhD in Genetics at UP. She then embarked on a two-year postdoctoral fellowship in the Department of Forest Mycology and Plant Pathology at the Swedish University of Agricultural Sciences in Uppsala, after which she returned to South Africa to take up a research fellowship at FABI. She is the author or co-author of 38 peer-reviewed articles in ISI-rated journals. Seven MSc and four PhD students have graduated under her supervision or co-supervision, and she is currently supervising or co-supervising three MSc and two PhD students. She also participates in mentorship programmes aimed at attracting students to postgraduate studies and cultivating the next generation of academics.
Dr Van der Nest received a C3 rating from the NRF.

Dr Visser is a senior lecturer in the Department of Animal and Wildlife Sciences in the Faculty of Natural and Agricultural Sciences.
She specialises in animal breeding and genetics and focuses on the genetic improvement of small stock, mainly by applying molecular techniques. The genetic improvement of animals in Africa to enhance their efficiency and adaptability will become crucial for food security, and she aims to play a part in overcoming the challenges that climate change will present to the human population. Dr Visser is the current vice-president of the International Goat Association, and received a bronze medal from the South African Society for Animal Science for her exceptional contribution to the advancement of professionalism and knowledge in animal science.
She has authored and co-authored 46 peer-reviewed articles published in national and international journals, and a further 11 published in popular media. She has been invited to make oral presentations at two international conferences, and to contribute two chapters on goat breeding and genetics to international textbooks. She was invited to write reviews for Small Ruminant Research in 2019, and for Animal Frontiers in 2020. She is registered with SACNASP as a professional animal scientist.
Dr Visser received a C1 rating from the NRF.

Professor Vorster is an associate professor in the Department of Plant and Soil Sciences in the Faculty of Natural and Agricultural Sciences. He leads the Molecular Plant Physiology research group in the Forestry and Agricultural Biotechnology Institute (FABI), as well as the South African Herbicide Resistance Initiative (SAHRI).
Since sustainable crop production in drier environments is becoming increasingly important under changing climate conditions, his research is focused on plant stress physiology, and in particular on how plants adapt to stress. Over the past 10 years his research group has studied the impact of drought on soybean crops and the ability of these plants to fix nitrogen under drought conditions. This has led to the identification of key genes that regulate development under stress and can be used to select more drought-tolerant cultivars. More recently his research has also included the study of herbicide-resistance mechanisms in weeds and the development of management strategies to ensure effective and sustainable crop production.
He is currently the president of the South African Society of Crop Production and serves on the management board of the South African Journal of Plant and Soil.
Prof Vorster received a C3 rating from the NRF.
Professor Wiese is a professor in the Department of Marketing Management. She holds a PhD in Marketing from the University of Pretoria.
Prof Wiese has published both locally and internationally and has produced many research articles and conference papers. In addition she has supervised several doctoral and master’s students. In 2017 she was awarded best senior researcher in Management Sciences by the Faculty of Economic and Management Sciences, and is also the recipient of a Laureate Award for Education Innovation.
She is a member of the South African Institute for Management Sciences (SAIMS) and external reviewer for many national and international marketing and business journals. Her research interest pertains to consumer behaviour with specific focus on how consumers make choices. Examples include on-line and off-line shopping choices, behaviour toward social media advertising, and choices concerning joining and engaging with on-line brand communities.
Prof Wiese received a C3 rating from the NRF.
Professor Zondi is an associate professor and head of the Department of African Languages at the University of Pretoria.
Using African languages as a platform to address gender inequalities in African societies in particular, she has transcended negative views that perceive African indigenous languages as having little or no value, especially in the literary world. She did this by adopting and applying literary theories widely used in well-known languages, such as English and Afrikaans, without compromising the discourses inherent in the relevant indigenous African languages. Challenging the hegemony of Eurocentric theories in addressing African problems, she is currently exploring techniques for moving away from such approaches by researching appropriate approaches using Afrocentric paradigms to address African problems.
She was identified and admitted to the 2019 University of Pretoria Programme for Academic Leadership (UP PAL) by the Vice-Chancellor, Prof Tawana Kupe, and has been awarded a Mellon Inclusive Professoriate Grant for the past three years. She used some of that funding to support a PhD candidate to expedite the completion of his studies.
Prof Zondi received a C2 rating from the NRF.





Dr Hussey is a senior lecturer in the Department of Biochemistry, Genetics and Microbiology in the Faculty of Natural and Agricultural Sciences and is affiliated with the Forestry and Agricultural Biotechnology Institute (FABI). Within the Forest Molecular Genetics Programme he leads a research group that studies the transcriptional and epigenetic regulation of wood formation, the molecular mechanisms by which genes, pathways and developmental programmes are dynamically controlled when cambial stem cells differentiate into fibres, vessels and other cell types. The ability to manipulate woody tissue development, for example through transgenic and synthetic biology approaches, creates exciting opportunities for tailoring woody biomass to specific product outputs for the multi-billion-rand pulp and paper industry. A Mandela Rhodes Scholar, Dr Hussey is also passionate about student innovation projects. He led two undergraduate UP teams to participate in the International Genetically Engineered Machines Competition, one of which won a silver medal at the 2016 Giant Jamboree in Boston, USA. He has also coordinated the Biomaker Challenge at UP, which seeks to create biological devices using open-source electronics, sensors and micro-controllers. He was accepted into the 2017 Tuks Young Research Leadership Programme and has received international funding through the Global Challenges Research Fund, the Australia Awards – Africa programme and the US Department of Energy Joint Genome Institute.
Dr Hussey received a P rating from the NRF.
Professor Makhalanyane is an associate professor in the Department of Biochemistry, Genetics and Microbiology in the Faculty of Natural and Agricultural Sciences. His scientific interests are focused primarily on central questions in the field of microbial ecology, genomics and biogeochemistry. He established the first South African research programme on the marine microbial ecology of the Southern Ocean.
His more than 45 publications have accrued more than 1 100 citations, and he has an H-index of 20. His articles have been published in the leading microbial ecology journals, including Microbiome, the ISME Journal, and Nature Microbiology. He has written several book chapters and reviews in FEMS Microbiology Reviews and Current Opinion in Biotechnology. He has received several awards, including the prestigious TW Kambule-NSTF Award and the International Society for Microbial Ecology Ambassador of the Year Award. With his recent election to the board of the International Society for Microbial Ecology (ISME) he became the first African to join the leadership of this body. Prof Makhalanyane serves as associate editor for Frontiers in Microbiology and mSystems, and is a reviewer for several journals. He also serves on various panels and has represented South Africa in international bilateral discussions. Since joining UP he has supervised or co-supervised 15 postgraduate students (eight honours, four master’s and three doctoral students) and hosted four postdoctoral researchers. He currently supervises 15 postgraduate students.
Prof Makhalanyane received a P rating from the NRF.
Professor Visagie is a new generation mycologist specialised in the taxonomy of Aspergillus, Penicillium, Talaromyces and other moulds from the natural and built environment. His research focus includes their biodiversity, ecology, phylogenetics, nomenclature and identification with a particular interest in taxonomically robust biodiversity studies. One of his major contributions to science has been the accepted species lists produced for Aspergillus, Penicillium and Talaromyces. Before these papers, describing new species in these genera was very complicated because of unavailable reference data. These papers had a significant international impact and have been cited a combined 1 305 times.
His research has shifted to exploit the modern and robust taxonomy they created for these important genera containing more than 1000 species and truly start exploring diversity around the world. Many of his projects characterise mycotoxigenic fungal communities related to important grain crops and developing methods to more efficiently monitor for these fungi and rapidly detect the species of interest. During this process, they are also expanding the CMW culture collection housed at the Forestry and Agricultural Biotechnology Institute with reference strains of grain-associated fungi that will be made available for a variety of future research projects. He is an active reviewer for international journals and serves on editorial boards for Studies in Mycology, Mycological Progress and Fungal Systematics and Evolution.
Prof Visagie received a P rating from the NRF.
Dr Barzegar is a senior researcher/EXXARO Junior Chair in the Department of Electrical, Electronic and Computer Engineering in the Faculty of Engineering, Built Environment and Information Technology.
He has been researching electrical energy storage fields for more than six years, with a particular focus on supercapacitor devices and applications. As part of his research he has been developing supercapacitors (SCs) as a potential device for hybrid energy storage system applications. Currently he is investigating a hybrid energy storage system application that might solve the problem of overheating and explosion associated with batteries. The output will potentially catalyse greater synergy between the researcher and the relevant industry, and result in a new generation of energy-storage devices.
His articles on research outputs have been published in top-ranking journals in his field. Based on the high quality of the aforementioned articles he has been invited as a keynote speaker at the International Conference on Innovative Applied Energy in the United Kingdom, and as a speaker at the 6th International Conference on Advanced Capacitors, held in Japan. In 2017 he was accepted as a participant in the Tuks Young Research Leader Programme. He has published more than 48 articles in international journals, has an h index of 20 (i10-index of 30), and is credited with more than 996 citations.
Dr Barzegar received a Y1 rating from the NRF.
Dr Bishop is an extraordinary lecturer in the Department of Zoology and Entomology whose research is focused on large-scale patterns and drivers of biodiversity.
He has a particular interest in the diversity of ants, and his research comprises three themes: First, he focuses on explaining patterns in species diversity. To this end, he is involved in a long-term ant monitoring project in the Sani Pass in the Maloti-Drakensberg, where he also runs experiments to establish how ants respond to changes in temperature and sodium availability. Second, he uses a trait-based approach to answer questions relating to biodiversity in an attempt to understand how variation in the characteristics of organisms may explain their distribution. Third, his research makes connections between the thermoregulatory abilities of ants and their activity, abundance and diversity across a range of environments. His work has shown how the simple biophysical properties of colour and size control the numbers of ants in different habitats. He pioneered a study conducted on 14 mountains on three continents, which revealed that in cold environments ant species have darker colours and larger bodies.
He is the recipient of Leverhulme Trust (UK) funding, and his 2017 paper on ant thermal physiology in the Maloti-Drakensberg Mountains was awarded ‘Best Paper over a two-year period’ by the editorial board of the journal Ecological Entomology
Dr Bishop received a Y2 rating from the NRF.
Dr Du Preez is a senior lecturer in the Tourism Management Division of the Department of Marketing Management. Her research focuses on destination marketing, sports tourism and events, and she has a specific interest in consumer research related to environmental behaviour and travel experiences.
She received a grant from the University of Pretoria’s Research Development Fund for the period 2018/2020, and has published in internationally recognised journals such as Current Issues in Tourism, Anatolia and the Journal of Sport & Tourism and Development Southern Africa. She has been involved in team research undertaken for the National Department of Tourism and South African National Parks, and has been both project leader and sole researcher for organisations such as the ATKV, CATHSSETA (Culture, Art, Tourism, Hospitality and Sports SETA), Sport and Recreation South Africa, Red Bull South Africa, Interkultur (owner of the World Choir Games), the City of Tshwane and the Tshwane Tourism Association.
Dr Du Preez received a Y2 rating from the NRF.




Dr Fabris-Rotelli is a senior lecturer in the Department of Statistics in the Faculty of Natural and Agricultural Sciences. She completed her PhD studies in 2013. Her current research involves the machine learning and big data aspects of spatial statistics for image processing and deals with the big data elements that theoretical spatial statistics has not yet fully acquired.
Her contribution to machine learning that uses spatial statistics is theoretical and can be implemented in all cases, as confirmed by her research outputs. Her research, which aims to promote the theoretical understanding of deep learning algorithms, has led to industry collaborations with Lightstone and ESRI South Africa. Her 2015 nomination to feature as one of the emerging women in science in a 2017 Department of Science and Technology publication is an acknowledgement of her standing in the academic environment.
She acted as a panellist during the South African Women in Mathematical Sciences Association workshop on ‘Harnessing the Leadership and Agency of Women in the Field for the Transformation Agenda’, presented in June 2019. In 2018 her leadership potential was recognised by her confirmation as a Tuks Young Researcher Leadership Programme fellow. She has an extensive postgraduate student supervision record.
Dr Fabris-Rotelli received a Y2 rating from the NRF.

Dr Gutura is a senior lecturer in social work in the Department of Social Work and Criminology in the Faculty of Humanities. She chairs the Department’s Transformation Committee, coordinates the social work tutor programme and serves on the Faculty’s Research Ethics Committee. In 2014, at the age of 27, she became the first young black female to obtain a PhD at the University of Fort Hare, and one of the first young black females to be awarded a doctoral degree in the field of social work in South Africa.
Her academic and research career commenced with her postdoctoral research, which focused on social assistance. Her unique contribution in this field is the finding that social assistance has a strong gender dimension in that it reaches more women than men. This shaped her scholarly focus and launched her gender-oriented research career. She hopes to continue developing her expertise to promote gender equality, the empowerment of women, and the fight against gender-based violence, in which women are mostly the victims.
Dr Gutura has published 16 articles in local and international journals and has contributed one chapter to a book. She has also supervised one PhD and nine master’s students. In 2017 she was selected for the NRF-UP Mentorship Programme for Black Academics.
Dr Gutura received a Y2 rating from the NRF.

Dr Hattingh is a senior lecturer in the Department of Informatics in the Faculty of Engineering, Built Environment and Information Technology. Her research is generally concerned with the role of social media in communities.
She takes an interdisciplinary view when applying either qualitative or quantitative approaches to study the following research focus areas: the use of social media to promote community safety, report crime, find missing persons and uplift communities. She also studies the use of social media in e-Government, the integration and use of social media by government institutions, the use of social media in e-Activism (namely how social media is used by online activists and the relationship with offline activism), the impact of social media on its users, positive and negative use of social media (dark web, fake news, narcissism and addiction), learning opportunities, and the moral and ethical consequences of social media use.
Some important recognition and awards she recently received from the Department of Informatics at the University of Pretoria include the highest student evaluation on postgraduate level (2019), a Teaching and Learning Excellence Award (2019), Highest Research Output (2017), and Highest Research Output (2019).
Dr Hattingh received a Y2 rating from the NRF.
Dr Heinze is a senior lecturer in the Department of Speech-Language Pathology and Audiology in the Faculty of Humanities and heads the University of Pretoria’s Vestibular Clinic and Neuro-Otologic Test Centre (NOTC), situated in the Department of SpeechLanguage Pathology and Audiology.
Her areas of research are in the fields of diagnostic audiology and vestibular science. She has a special interest in how communicable diseases such as HIV/AIDS, non-communicable diseases such as diabetes mellitus, and medication for tuberculosis and cancer affect hearing, the vestibular system and balance. Her research area further includes objective assessments and surveillance of vestibular function and its mobile application within various health care settings, specifically in infectious disease clinics and oncology units.
Dr Heinze is the primary grant holder of the NRF’s National Equipment Programme (NEP) for Africa’s first and only state-of-the-art specialist NOTC and rotary chair. This NOTC has allowed and continues to allow novel, ground-breaking research and opportunities for international collaboration and exposure. She also received a R1.5 million research grant from the Oticon Foundation, which provided funding for several postgraduate student research projects and resulted in international publications. Dr Heinze serves on the editorial board of Neuro-Otology as review editor for the journal Frontiers in Neurology. She is also the editor of the Journal of HIV for Clinical and Scientific Research.
Dr Heinze received a Y2 rating from the NRF.
Dr Hoffman is a lecturer in the Department of Consumer and Food Sciences.
Her discipline is human nutrition. She is a member of a research team involved in a prospective cohort study to determine the nutrition-related phenotypic outcomes for children (from conception to two years of age) who have been exposed to HIV (HEU) and antiretroviral therapy (ART) in utero without being themselves HIV-infected, in relation to the mothers’ nutritional status and breast milk macro-nutrient composition.
Her field of specialisation is the assessment of how dietary intake influences micronutrient malnutrition and psychomotor development during infancy and early childhood in low-income communities in South Africa. Her research on the dietary and feeding practices of infants and young children in the aforementioned communities can be considered in three different focus areas: dietary intake, growth and development, and nutritional status with regard to micronutrient intake. Optimal feeding practices are known to result in a healthy nutritional status during the crucial time of brain development and growth in infants and young children.
Dr Hoffman received a Y2 rating from the NRF.
Dr Mahomed Asmail is a senior lecturer in the Department of Speech-Language Pathology and Audiology, Faculty of Humanities. Her main research interests relate to tele- and m-health solutions to improve access to ear and hearing health care.
Dr Mahomed Asmail completed her master’s degree in this field in 18 months and her doctorate in two and a half years. More recently, her research has expanded to investigate the biopsychosocial approach in Patient/Relationship Centered Care.
She is a young researcher (30 years old) with growing national and international recognition. She has published 16 articles in Clarivate Analytics Web of Science(previously called ISI) accredited journals, which are some of the leading subject-specific journals in the field of Audiology. Dr Mahomed Asmail has also written four chapters for international open access books. Additionally, her work has been presented both at a national and international level.
Dr Mahomed Asmail has won the Audiology Doctorate research prize at the Ear Nose and Throat/South African Academy of Audiology congress, as well as the Emerging Researcher award for the Faculty of Humanities, University of Pretoria, in 2017.
In 2019 Dr Mahomed Asmail was awarded the Mellon Inclusive Professoriate grant for the period 2019-2021.
Dr Mahomed Asmail received a Y1 rating from the NRF.




Dr Marx-Pienaar is a lecturer in the Department of Consumer and Food Sciences at the University of Pretoria, where she teaches research design and methodology, food retail logistics, supply chain management and the consumer aspects of food.
Her previous employment and industry experience in both hospitality and retail helped in her master’s and doctoral studies, which focused on consumer satisfaction and, more importantly, the sustainability of consumers’ consumption and wasteful practices. She is currently an active research member of the Department of Science and Technology/ National Research Foundation’s Centre of Excellence in Food Security. Her other collaborative relationships and industry partners include key retail groups and their supply chain members, the CSIR, the WWF and prominent international universities.
Her main research focus relates to sustainable consumption and corporate social responsibility. Other interests include the mitigation of food waste, consumer behaviour and profile mapping, food product development, marketing and life cycle analysis. She is currently supervising one PhD and seven master’s students.
Dr Marx-Pienaar received a Y2 NRF rating from the NRF.

Dr Mawela is a senior lecturer and MIT ICT Management programme coordinator in the Department of Informatics, which is part of the School of Information Technology in the Faculty of Engineering, Built Environment and Information Technology (EBIT).
She completed an MBA degree at the Wits Business School and a PhD at the University of Pretoria. Her primary research interests are in the application of information and communication technologies (ICTs) for social and economic development, digital skills and digital inclusion.
Her research also focuses on the public value of e-government and the use of technology to support government operations, service delivery, citizen participation and governance. She is a principal researcher for the K4I Digital Skills Research Project of the National Electronic Media Institute of South Africa (NEMISA), which concentrates on initiatives that develop South African citizens’ digital skills capacity. She currently serves as a member on the council of the South African Institute of Computer Scientists and Information Technologists (SAICSIT) and has professional membership of the Association for Information Systems (AIS). She has served as conference co-chair and organising committee member for the e-Skills Colloquium since 2018.
Dr Mawela received a Y2 rating from the NRF.

Dr Mehrabi is a senior lecturer in the Department of Mechanical and Aeronautical Engineering and a member of the Clean Energy Research Group in the Faculty of Engineering, Built Environment and Information Technology (EBIT). His research interests include heat transfer and fluid mechanics, computational fluid dynamics (CFD), microfluidics and their applications in the field of biomedical engineering, and modelling and optimisation based on artificial intelligence (AI) techniques. He also conducts research in the fields of clean and renewable energy, energy efficiency based on multi-objective optimisation techniques, and the application of machine learning methods in mechanical and biomedical engineering.
Peer-reviewed papers on his research projects have been published in more than 20 international mechanical engineering journals, and he has presented his research results at prominent international conferences around the world. The number of citations accredited to him, as well as his h-index, attest to the high quality of his research outputs. He has successfully supervised more than 50 undergraduate and postgraduate students at the University of Pretoria and regularly serves as a member of the examination committee for master’s and PhD candidates.
Dr Mehrabi received a Y1 rating from the NRF.
Dr Messerschmidt, a lecturer in the Department of Mathematics and Applied Mathematics in the Faculty of Natural and Agricultural Science, specialises in functional analysis, which is a field of mathematics that studies infinite-dimensional vector spaces. His most recent research relates to Lipschitz geometry, a field that studies functions that are more than just continuous, but less than differentiable. He has also undertaken minor research in the field of computational geometry.
Together with his postgraduate students he continues to explore his broader mathematical interests, which currently include ergodic theory and computational algebra. The former is a subject that originated in physics but has proven to have wide application in number theory. His interest in the latter is focused on algorithms for computing so-called ‘Groebner bases of systems of polynomial equations’, which generalise the famous Gauss elimination algorithm for systems of linear equations.
Dr Messerschmidt received a Y1 rating from the NRF.
Dr Moghimi Ardekani is an Associate Professor in the Department of Engineering and Design at Staffordshire University in the UK and an extraordinary lecturer in the Department of Mechanical and Aeronautical Engineering at the University of Pretoria.
Since 2013 he has been actively involved in the design and optimisation of new technologies and devices in the following fields: renewable energy (solar thermal technologies in particular), thermal energy storage, and multiphase-based (including nanofluid) heat sinks. His collaborations and consultations with various research institutes and companies around the world have led to the publication of 50 papers in top peerreviewed journals and prestigious conference proceedings. He is also the author of one book, two chapters in books and a webinar.
According to Google Scholar, his research findings have been cited 380 times, and he has an h index of 11, which has earned him the international Green Talent Award of the German Federal Ministry of Education and Research (BMBF).
Dr Moghimi Ardekani received a Y2 rating from the NRF.
Dr Oosthuizen is a senior lecturer in the Department of Zoology and Entomology, Faculty of Natural and Agricultural Sciences.
He mainly focuses on molecular phylogenetics, population genetics and conservation biology, specifically in the aquatic environment. He is interested in identifying the evolutionary processes that have shaped genetic diversity, its distribution and the patterns that can be observed today.
His research mainly focuses on the genetic diversity and population structure of four marine fish species (Teleostei: Sparidae) along the southern African coast. During his research career he has been exposed to a number of additional projects that extensively increased his experience in the laboratory and with different systems. The major projects that he is currently involved with, in addition to his own research, are phylogenetic and phylogeography studies on golden moles (Chrysochloridae), the genome-wide effect of artificial selection using the Mediterranean fruit fly (Ceratitis capitate) and freshwater yellowfish (Labeobarbus natalensis). As part of the yellowfish project on Labeobarbus natalensis, a novel approach is used with next generation sequencing by performing restriction-site associated DNA tags for single nucleotide polymorphism detection across the whole genome.
Dr Oosthuizen received a Y2 rating from the NRF.

Dr Miek Messerschmidt



Dr Prinsloo is a senior lecturer in the Department of Informatics in the Faculty of Engineering, Built Environment and Information Technology.
Her research focuses mainly on the use of information and communication technologies (ICTs) in agriculture, which includes the use of smart technologies such as drones for surveillance on farms, food safety, and tracing and identifying animals for export. For her PhD, completed in 2017, she investigated the impact and sustainability of livestock traceability systems in Namibia and Eswatini. In 2018 she was awarded a Newton Grant, which enabled her to spend six weeks at the University of Reading in the UK, where she worked with colleagues from the School of Agriculture, Policy and Development.
She continues to collaborate with them with regard to establishing the eating behaviour of cattle in Eswatini, including their water consumption and rumination times, depending on specific food intake. This will be done by fitting selected cattle with a rumination collar and a pedometer (a device that determines walking behaviour). The pedometer can also predict lameness or restlessness in animals. The animals’ locations and the distances covered in search of fresh water can be tracked by using a GPS. She aims to continue her research in line with the Sustainable Development Goals.
Dr Prinsloo received a Y2 rating from the NRF.

Dr Steyn left industry 11 years ago to join the staff of the University of Pretoria. She is currently a full-time senior lecturer in the Department of Informatics and has, through the years, presented both undergraduate and postgraduate modules.
Her research focuses mainly on the use of technology in education in the business analysis and design space, and on how she can more effectively engage students while still presenting quality content.
Her different approach to teaching was the result of her passion for research on entrepreneurship. She has developed a framework to assist SMEs to engage more effectively with technology, as well as a course in e-skills for entrepreneurs, which focuses on effective technology engagement to create sustainable businesses.
She has published various articles based on her teaching experiences and has supervised many students, including her first PhD student in 2016. In 2018 she received an Association of Information Systems Award for Innovation in Teaching (an international award) and in 2019 she was the recipient of a UP Laureate Award for excellence in teaching.
Dr Steyn received a Y2 rating from the NRF.
This year the University of Pretoria introduced three new awards under The Conversation Africa Science Communication Awards category. The Conversation Africa gives all higher education institutions an opportunity to share their research outputs with fellow academics across the globe as well as with civil society. The platform therefore places academics in a better position to identify opportunities to collaborate and conduct research with their peers across disciplines. Our partnership with The Conversation has increased the visibility of the work of UP researchers and academics, helping them reach wider audiences beyond academic research communities.
The award winners for the period of 1 January 2019 - 31 December 2019.
UP Author with the most articles published on The Conversation in 2019, the award goes to Professor Henning Melber. He had 7 articles for the period under review.
Professor Melber studied Political Sciences and Sociology at the Freie Universität Berlin. He obtained his doctorate in political sciences and a habilitation in development studies at the University of Bremen. He was Director of The Namibian Economic Policy Research Unit in Windhoek, is director emeritus of the Dag Hammarskjöld Foundation and a former research director of the Nordic Africa Institute, and remains affiliated to both institutions in Uppsala, Sweden as a senior advisor. He is extraordinary professor at the Department of Political Sciences at UP and the Centre for Gender and Africa Studies at the University of the Free State, senior research fellow at the Institute for Commonwealth Studies/Centre for Advanced Study of the University of London, and current President of the European Association of Development Research and Training Institutes (EADI). His research interests in African and Development Studies include civil and human rights, global governance, (post)colonialism and racism. Prof Melber has published over 50 monographs and (co-)edited volumes, and more than 500 journal articles and book chapters, mainly on Namibia and Southern Africa, African social and policy issues and the legacy of Dag Hammarskjöld.
The most read article on The Conversation in 2019, the award goes to Professor Fransjohan Pretorius who garnered 231 299 readers with his article Concentration camps in the South African War? Here are the real facts.
Professor Pretorius is an emeritus professor in the Department of Historical and Heritage Studies. He is a University of Pretoria alumnus who also studied at the University of Leiden in the Netherlands, and received his PhD from Unisa. He was a lecturer in the Department of Historical and Heritage Studies from 1989 until his retirement in 2014. His field of research is the Anglo-Boer War, and he has written or edited eight books on the war. He is the editor of A History of South Africa: From the Distant Past to the Present Day (2014). He has received several awards and was the runner-up of the Sunday Times Alan Paton Award for Life on Commando during the Anglo-Boer War 1899-1902. Prof Pretorius has published hundreds of papers and also appears on radio programmes. His work on commando life during the South African War is internationally recognised as one of the most important investigations into that period. Scorched Earth, the illustrated book based on that period, attracted widespread attention. In 2019 he was awarded the Jan H Marais Prize for Outstanding contribution to Afrikaans as an academic language. In 2020 his Terugblik: 80 sketse uit ‘n ryk verlede was published by Protea Boekhuis.
Most commented on story or article with the most engagements based on comments made by readers on the TC-Africa sit. The award goes to Dr Quixi Sonntag for her Curious Kids article titled: Do cats and dogs understand us when we miaow or bark?
Dr Sonntag was a lecturer in animal behaviour and welfare from 2008 to 2019 in the Department of Companion Animal Clinical Studies, where she established the Onderstepoort Behaviour Clinic. She became Community Engagement Coordinator for the Faculty of Veterinary Science in the Department of Production Animal Studies in January 2020. She teaches veterinary science and veterinary nursing students in community engagement, animal welfare, and wellness and communication skills. Dr Sonntag was the first veterinarian in South Africa to establish a veterinary practice dealing exclusively with behaviour disorders in pets. Here she learned that dealing with humans is a big part of fixing a pet’s behaviour problem. This interest in the human side of veterinary science further led to an interest in community veterinary work, and Dr Sonntag established the Winterveld Community Veterinary Clinic under the auspices of the South African Veterinary Association in the early 2000s.



The evaluation and rating of individuals is based primarily on the quality of the research outputs and is undertaken by national and international peers/reviewers.






